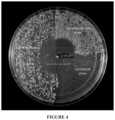

US12011469B2 - Parenteral delivery device and methods of use - Google Patents
Parenteral delivery device and methods of useDownload PDFInfo
- Publication number
- US12011469B2 US12011469B2US15/987,729US201815987729AUS12011469B2US 12011469 B2US12011469 B2US 12011469B2US 201815987729 AUS201815987729 AUS 201815987729AUS 12011469 B2US12011469 B2US 12011469B2
- Authority
- US
- United States
- Prior art keywords
- compartment
- delivery device
- capsule
- lactobacillus
- percent
- Prior art date
- Legal status (The legal status is an assumption and is not a legal conclusion. Google has not performed a legal analysis and makes no representation as to the accuracy of the status listed.)
- Active
Links
- 238000000034methodMethods0.000titleabstractdescription14
- 239000002002slurrySubstances0.000claimsdescription78
- 239000002775capsuleSubstances0.000claimsdescription77
- 239000006041probioticSubstances0.000claimsdescription45
- 235000018291probioticsNutrition0.000claimsdescription45
- 239000000843powderSubstances0.000claimsdescription42
- 239000003921oilSubstances0.000claimsdescription41
- 235000019198oilsNutrition0.000claimsdescription41
- 235000019722synbioticsNutrition0.000claimsdescription40
- KGBXLFKZBHKPEV-UHFFFAOYSA-Nboric acidChemical compoundOB(O)OKGBXLFKZBHKPEV-UHFFFAOYSA-N0.000claimsdescription35
- 235000013406prebioticsNutrition0.000claimsdescription34
- 235000010338boric acidNutrition0.000claimsdescription31
- 238000004090dissolutionMethods0.000claimsdescription31
- 230000000529probiotic effectEffects0.000claimsdescription31
- 208000034423DeliveryDiseases0.000claimsdescription12
- 230000009677vaginal deliveryEffects0.000claimsdescription12
- 241000218492Lactobacillus crispatusSpecies0.000claimsdescription9
- 241000186606Lactobacillus gasseriSpecies0.000claimsdescription9
- 241001324870Lactobacillus inersSpecies0.000claimsdescription8
- 241001561398Lactobacillus jenseniiSpecies0.000claimsdescription8
- 239000003240coconut oilSubstances0.000claimsdescription8
- 235000019864coconut oilNutrition0.000claimsdescription8
- FTSSQIKWUOOEGC-RULYVFMPSA-NfructooligosaccharideChemical compoundOC[C@H]1O[C@@](CO)(OC[C@@]2(OC[C@@]3(OC[C@@]4(OC[C@@]5(OC[C@@]6(OC[C@@]7(OC[C@@]8(OC[C@@]9(OC[C@@]%10(OC[C@@]%11(O[C@H]%12O[C@H](CO)[C@@H](O)[C@H](O)[C@H]%12O)O[C@H](CO)[C@@H](O)[C@@H]%11O)O[C@H](CO)[C@@H](O)[C@@H]%10O)O[C@H](CO)[C@@H](O)[C@@H]9O)O[C@H](CO)[C@@H](O)[C@@H]8O)O[C@H](CO)[C@@H](O)[C@@H]7O)O[C@H](CO)[C@@H](O)[C@@H]6O)O[C@H](CO)[C@@H](O)[C@@H]5O)O[C@H](CO)[C@@H](O)[C@@H]4O)O[C@H](CO)[C@@H](O)[C@@H]3O)O[C@H](CO)[C@@H](O)[C@@H]2O)[C@@H](O)[C@@H]1OFTSSQIKWUOOEGC-RULYVFMPSA-N0.000claimsdescription6
- 229940107187fructooligosaccharideDrugs0.000claimsdescription6
- 229920001542oligosaccharidePolymers0.000claimsdescription6
- 239000003755preservative agentSubstances0.000claimsdescription6
- 230000002335preservative effectEffects0.000claimsdescription5
- 239000000829suppositorySubstances0.000claimsdescription4
- 229920001202InulinPolymers0.000claimsdescription3
- 230000001847bifidogenic effectEffects0.000claimsdescription3
- HEBKCHPVOIAQTA-NGQZWQHPSA-Nd-xylitolChemical compoundOC[C@H](O)C(O)[C@H](O)COHEBKCHPVOIAQTA-NGQZWQHPSA-N0.000claimsdescription3
- 235000021255galacto-oligosaccharidesNutrition0.000claimsdescription3
- 150000003271galactooligosaccharidesChemical class0.000claimsdescription3
- JYJIGFIDKWBXDU-MNNPPOADSA-NinulinChemical compoundO[C@H]1[C@H](O)[C@@H](CO)O[C@@]1(CO)OC[C@]1(OC[C@]2(OC[C@]3(OC[C@]4(OC[C@]5(OC[C@]6(OC[C@]7(OC[C@]8(OC[C@]9(OC[C@]%10(OC[C@]%11(OC[C@]%12(OC[C@]%13(OC[C@]%14(OC[C@]%15(OC[C@]%16(OC[C@]%17(OC[C@]%18(OC[C@]%19(OC[C@]%20(OC[C@]%21(OC[C@]%22(OC[C@]%23(OC[C@]%24(OC[C@]%25(OC[C@]%26(OC[C@]%27(OC[C@]%28(OC[C@]%29(OC[C@]%30(OC[C@]%31(OC[C@]%32(OC[C@]%33(OC[C@]%34(OC[C@]%35(OC[C@]%36(O[C@@H]%37[C@@H]([C@@H](O)[C@H](O)[C@@H](CO)O%37)O)[C@H]([C@H](O)[C@@H](CO)O%36)O)[C@H]([C@H](O)[C@@H](CO)O%35)O)[C@H]([C@H](O)[C@@H](CO)O%34)O)[C@H]([C@H](O)[C@@H](CO)O%33)O)[C@H]([C@H](O)[C@@H](CO)O%32)O)[C@H]([C@H](O)[C@@H](CO)O%31)O)[C@H]([C@H](O)[C@@H](CO)O%30)O)[C@H]([C@H](O)[C@@H](CO)O%29)O)[C@H]([C@H](O)[C@@H](CO)O%28)O)[C@H]([C@H](O)[C@@H](CO)O%27)O)[C@H]([C@H](O)[C@@H](CO)O%26)O)[C@H]([C@H](O)[C@@H](CO)O%25)O)[C@H]([C@H](O)[C@@H](CO)O%24)O)[C@H]([C@H](O)[C@@H](CO)O%23)O)[C@H]([C@H](O)[C@@H](CO)O%22)O)[C@H]([C@H](O)[C@@H](CO)O%21)O)[C@H]([C@H](O)[C@@H](CO)O%20)O)[C@H]([C@H](O)[C@@H](CO)O%19)O)[C@H]([C@H](O)[C@@H](CO)O%18)O)[C@H]([C@H](O)[C@@H](CO)O%17)O)[C@H]([C@H](O)[C@@H](CO)O%16)O)[C@H]([C@H](O)[C@@H](CO)O%15)O)[C@H]([C@H](O)[C@@H](CO)O%14)O)[C@H]([C@H](O)[C@@H](CO)O%13)O)[C@H]([C@H](O)[C@@H](CO)O%12)O)[C@H]([C@H](O)[C@@H](CO)O%11)O)[C@H]([C@H](O)[C@@H](CO)O%10)O)[C@H]([C@H](O)[C@@H](CO)O9)O)[C@H]([C@H](O)[C@@H](CO)O8)O)[C@H]([C@H](O)[C@@H](CO)O7)O)[C@H]([C@H](O)[C@@H](CO)O6)O)[C@H]([C@H](O)[C@@H](CO)O5)O)[C@H]([C@H](O)[C@@H](CO)O4)O)[C@H]([C@H](O)[C@@H](CO)O3)O)[C@H]([C@H](O)[C@@H](CO)O2)O)[C@@H](O)[C@H](O)[C@@H](CO)O1JYJIGFIDKWBXDU-MNNPPOADSA-N0.000claimsdescription3
- 229940029339inulinDrugs0.000claimsdescription3
- DLRVVLDZNNYCBX-RTPHMHGBSA-NisomaltoseChemical compoundO[C@@H]1[C@@H](O)[C@H](O)[C@@H](CO)O[C@@H]1OC[C@@H]1[C@@H](O)[C@H](O)[C@@H](O)C(O)O1DLRVVLDZNNYCBX-RTPHMHGBSA-N0.000claimsdescription3
- JCQLYHFGKNRPGE-FCVZTGTOSA-NlactuloseChemical compoundOC[C@H]1O[C@](O)(CO)[C@@H](O)[C@@H]1O[C@H]1[C@H](O)[C@@H](O)[C@@H](O)[C@@H](CO)O1JCQLYHFGKNRPGE-FCVZTGTOSA-N0.000claimsdescription3
- 229960000511lactuloseDrugs0.000claimsdescription3
- PFCRQPBOOFTZGQ-UHFFFAOYSA-Nlactulose keto formNatural productsOCC(=O)C(O)C(C(O)CO)OC1OC(CO)C(O)C(O)C1OPFCRQPBOOFTZGQ-UHFFFAOYSA-N0.000claimsdescription3
- 150000002482oligosaccharidesChemical class0.000claimsdescription3
- 238000011282treatmentMethods0.000abstractdescription23
- 206010046914Vaginal infectionDiseases0.000abstractdescription7
- 230000007246mechanismEffects0.000abstractdescription5
- 230000009471actionEffects0.000abstractdescription3
- 239000000463materialSubstances0.000description65
- 239000002609mediumSubstances0.000description35
- 210000005002female reproductive tractAnatomy0.000description27
- 241000186660LactobacillusSpecies0.000description26
- 208000037265diseases, disorders, signs and symptomsDiseases0.000description22
- 241000894006BacteriaSpecies0.000description18
- 201000007096Vulvovaginal CandidiasisDiseases0.000description17
- 241000222122Candida albicansSpecies0.000description15
- 230000000694effectsEffects0.000description15
- 201000010099diseaseDiseases0.000description14
- 239000000203mixtureSubstances0.000description13
- 239000007787solidSubstances0.000description12
- 208000024891symptomDiseases0.000description12
- 239000008188pelletSubstances0.000description11
- 208000004926Bacterial VaginosisDiseases0.000description9
- 208000037009Vaginitis bacterialDiseases0.000description9
- 230000000843anti-fungal effectEffects0.000description9
- 208000015181infectious diseaseDiseases0.000description9
- 229940039696lactobacillusDrugs0.000description9
- 239000010677tea tree oilSubstances0.000description9
- 229940111630tea tree oilDrugs0.000description9
- 229940095731candida albicansDrugs0.000description8
- 239000007788liquidSubstances0.000description8
- 229940121375antifungal agentDrugs0.000description7
- 238000000576coating methodMethods0.000description7
- 208000035475disorderDiseases0.000description7
- 150000002632lipidsChemical class0.000description7
- 108010010803GelatinProteins0.000description6
- 240000004808Saccharomyces cerevisiaeSpecies0.000description6
- 239000003814drugSubstances0.000description6
- 229920000159gelatinPolymers0.000description6
- 239000008273gelatinSubstances0.000description6
- 235000019322gelatineNutrition0.000description6
- 235000011852gelatine dessertsNutrition0.000description6
- 229920003088hydroxypropyl methyl cellulosePolymers0.000description6
- 239000011343solid materialSubstances0.000description6
- 206010017533Fungal infectionDiseases0.000description5
- 229920002472StarchPolymers0.000description5
- 239000002253acidSubstances0.000description5
- 239000002585baseSubstances0.000description5
- 230000003115biocidal effectEffects0.000description5
- 238000003501co-cultureMethods0.000description5
- 239000007902hard capsuleSubstances0.000description5
- 241000196324EmbryophytaSpecies0.000description4
- 241000233866FungiSpecies0.000description4
- 239000006142Luria-Bertani AgarSubstances0.000description4
- VYPSYNLAJGMNEJ-UHFFFAOYSA-NSilicium dioxideChemical compoundO=[Si]=OVYPSYNLAJGMNEJ-UHFFFAOYSA-N0.000description4
- 239000003242anti bacterial agentSubstances0.000description4
- 229940088710antibiotic agentDrugs0.000description4
- 230000009286beneficial effectEffects0.000description4
- 239000011248coating agentSubstances0.000description4
- 230000003111delayed effectEffects0.000description4
- 238000009472formulationMethods0.000description4
- 230000005764inhibitory processEffects0.000description4
- 239000000546pharmaceutical excipientSubstances0.000description4
- 230000002265preventionEffects0.000description4
- 241000894007speciesSpecies0.000description4
- 235000019698starchNutrition0.000description4
- 229940120293vaginal suppositoryDrugs0.000description4
- 239000006216vaginal suppositorySubstances0.000description4
- 229910015444B(OH)3Inorganic materials0.000description3
- 241000222120Candida <Saccharomycetales>Species0.000description3
- VEXZGXHMUGYJMC-UHFFFAOYSA-NHydrochloric acidChemical compoundClVEXZGXHMUGYJMC-UHFFFAOYSA-N0.000description3
- 239000006137Luria-Bertani brothSubstances0.000description3
- 241000222126[Candida] glabrataSpecies0.000description3
- 230000000656anti-yeastEffects0.000description3
- 239000004327boric acidSubstances0.000description3
- 208000032343candida glabrata infectionDiseases0.000description3
- 239000006071creamSubstances0.000description3
- 229940079593drugDrugs0.000description3
- 239000004615ingredientSubstances0.000description3
- 230000000670limiting effectEffects0.000description3
- 238000002483medicationMethods0.000description3
- 239000008107starchSubstances0.000description3
- 239000000375suspending agentSubstances0.000description3
- 239000000725suspensionSubstances0.000description3
- 229940124597therapeutic agentDrugs0.000description3
- 210000001215vaginaAnatomy0.000description3
- WRYLYDPHFGVWKC-UHFFFAOYSA-N4-terpineolChemical compoundCC(C)C1(O)CCC(C)=CC1WRYLYDPHFGVWKC-UHFFFAOYSA-N0.000description2
- 229920001817AgarPolymers0.000description2
- CIWBSHSKHKDKBQ-JLAZNSOCSA-NAscorbic acidChemical compoundOC[C@H](O)[C@H]1OC(=O)C(O)=C1OCIWBSHSKHKDKBQ-JLAZNSOCSA-N0.000description2
- 229920002261Corn starchPolymers0.000description2
- WEEGYLXZBRQIMU-UHFFFAOYSA-NEucalyptolChemical compoundC1CC2CCC1(C)OC2(C)CWEEGYLXZBRQIMU-UHFFFAOYSA-N0.000description2
- PEDCQBHIVMGVHV-UHFFFAOYSA-NGlycerolNatural productsOCC(O)COPEDCQBHIVMGVHV-UHFFFAOYSA-N0.000description2
- MHAJPDPJQMAIIY-UHFFFAOYSA-NHydrogen peroxideChemical compoundOOMHAJPDPJQMAIIY-UHFFFAOYSA-N0.000description2
- 240000001046Lactobacillus acidophilusSpecies0.000description2
- 235000013956Lactobacillus acidophilusNutrition0.000description2
- 241000186679Lactobacillus buchneriSpecies0.000description2
- 244000199866Lactobacillus caseiSpecies0.000description2
- 235000013958Lactobacillus caseiNutrition0.000description2
- 241000186840Lactobacillus fermentumSpecies0.000description2
- 240000006024Lactobacillus plantarumSpecies0.000description2
- 235000013965Lactobacillus plantarumNutrition0.000description2
- 241000186869Lactobacillus salivariusSpecies0.000description2
- 235000019501Lemon oilNutrition0.000description2
- 235000019759Maize starchNutrition0.000description2
- 240000003183Manihot esculentaSpecies0.000description2
- 235000016735Manihot esculenta subsp esculentaNutrition0.000description2
- 241001465754MetazoaSpecies0.000description2
- BYBLEWFAAKGYCD-UHFFFAOYSA-NMiconazoleChemical compoundClC1=CC(Cl)=CC=C1COC(C=1C(=CC(Cl)=CC=1)Cl)CN1C=NC=C1BYBLEWFAAKGYCD-UHFFFAOYSA-N0.000description2
- KAESVJOAVNADME-UHFFFAOYSA-NPyrroleChemical compoundC=1C=CNC=1KAESVJOAVNADME-UHFFFAOYSA-N0.000description2
- FAPWRFPIFSIZLT-UHFFFAOYSA-MSodium chlorideChemical compound[Na+].[Cl-]FAPWRFPIFSIZLT-UHFFFAOYSA-M0.000description2
- 244000061456Solanum tuberosumSpecies0.000description2
- 235000002595Solanum tuberosumNutrition0.000description2
- 240000008042Zea maysSpecies0.000description2
- 235000005824Zea mays ssp. parviglumisNutrition0.000description2
- 235000002017Zea mays subsp maysNutrition0.000description2
- 239000008272agarSubstances0.000description2
- 230000001032anti-candidal effectEffects0.000description2
- 230000008901benefitEffects0.000description2
- 239000001506calcium phosphateSubstances0.000description2
- 235000010418carrageenanNutrition0.000description2
- 239000000679carrageenanSubstances0.000description2
- 229920001525carrageenanPolymers0.000description2
- 229940113118carrageenanDrugs0.000description2
- 239000010630cinnamon oilSubstances0.000description2
- VNFPBHJOKIVQEB-UHFFFAOYSA-NclotrimazoleChemical compoundClC1=CC=CC=C1C(N1C=NC=C1)(C=1C=CC=CC=1)C1=CC=CC=C1VNFPBHJOKIVQEB-UHFFFAOYSA-N0.000description2
- 235000005822cornNutrition0.000description2
- 238000011161developmentMethods0.000description2
- 230000018109developmental processEffects0.000description2
- 229940011871estrogenDrugs0.000description2
- 239000000262estrogenSubstances0.000description2
- 229960004884fluconazoleDrugs0.000description2
- RFHAOTPXVQNOHP-UHFFFAOYSA-NfluconazoleChemical compoundC1=NC=NN1CC(C=1C(=CC(F)=CC=1)F)(O)CN1C=NC=N1RFHAOTPXVQNOHP-UHFFFAOYSA-N0.000description2
- 210000001035gastrointestinal tractAnatomy0.000description2
- -1glycerol esterChemical class0.000description2
- 239000008187granular materialSubstances0.000description2
- 239000008169grapeseed oilSubstances0.000description2
- 230000002401inhibitory effectEffects0.000description2
- 229910052500inorganic mineralInorganic materials0.000description2
- JVTAAEKCZFNVCJ-UHFFFAOYSA-Nlactic acidChemical compoundCC(O)C(O)=OJVTAAEKCZFNVCJ-UHFFFAOYSA-N0.000description2
- 229940039695lactobacillus acidophilusDrugs0.000description2
- 229940017800lactobacillus caseiDrugs0.000description2
- 229940012969lactobacillus fermentumDrugs0.000description2
- 229940072205lactobacillus plantarumDrugs0.000description2
- 239000010501lemon oilSubstances0.000description2
- 239000011159matrix materialSubstances0.000description2
- 239000001525mentha piperita l. herb oilSubstances0.000description2
- LXCFILQKKLGQFO-UHFFFAOYSA-NmethylparabenChemical compoundCOC(=O)C1=CC=C(O)C=C1LXCFILQKKLGQFO-UHFFFAOYSA-N0.000description2
- 244000005700microbiomeSpecies0.000description2
- 239000011859microparticleSubstances0.000description2
- 239000011707mineralSubstances0.000description2
- 238000012986modificationMethods0.000description2
- 230000004048modificationEffects0.000description2
- 239000010661oregano oilSubstances0.000description2
- 229940111617oregano oilDrugs0.000description2
- 235000019477peppermint oilNutrition0.000description2
- 229920000642polymerPolymers0.000description2
- QELSKZZBTMNZEB-UHFFFAOYSA-NpropylparabenChemical compoundCCCOC(=O)C1=CC=C(O)C=C1QELSKZZBTMNZEB-UHFFFAOYSA-N0.000description2
- 239000002994raw materialSubstances0.000description2
- 230000009467reductionEffects0.000description2
- 239000000377silicon dioxideSubstances0.000description2
- 235000012239silicon dioxideNutrition0.000description2
- 235000010339sodium tetraborateNutrition0.000description2
- 239000007901soft capsuleSubstances0.000description2
- 238000012360testing methodMethods0.000description2
- 238000002560therapeutic procedureMethods0.000description2
- QORWJWZARLRLPR-UHFFFAOYSA-Htricalcium bis(phosphate)Chemical class[Ca+2].[Ca+2].[Ca+2].[O-]P([O-])([O-])=O.[O-]P([O-])([O-])=OQORWJWZARLRLPR-UHFFFAOYSA-H0.000description2
- XLYOFNOQVPJJNP-UHFFFAOYSA-NwaterSubstancesOXLYOFNOQVPJJNP-UHFFFAOYSA-N0.000description2
- 210000005253yeast cellAnatomy0.000description2
- UHVMMEOXYDMDKI-JKYCWFKZSA-Lzinc;1-(5-cyanopyridin-2-yl)-3-[(1s,2s)-2-(6-fluoro-2-hydroxy-3-propanoylphenyl)cyclopropyl]urea;diacetateChemical compound[Zn+2].CC([O-])=O.CC([O-])=O.CCC(=O)C1=CC=C(F)C([C@H]2[C@H](C2)NC(=O)NC=2N=CC(=CC=2)C#N)=C1OUHVMMEOXYDMDKI-JKYCWFKZSA-L0.000description2
- YHQGMYUVUMAZJR-UHFFFAOYSA-Nα-terpineneChemical compoundCC(C)C1=CC=C(C)CC1YHQGMYUVUMAZJR-UHFFFAOYSA-N0.000description2
- YKFLAYDHMOASIY-UHFFFAOYSA-Nγ-terpineneChemical compoundCC(C)C1=CCC(C)=CC1YKFLAYDHMOASIY-UHFFFAOYSA-N0.000description2
- BLSQLHNBWJLIBQ-OZXSUGGESA-N(2R,4S)-terconazoleChemical compoundC1CN(C(C)C)CCN1C(C=C1)=CC=C1OC[C@@H]1O[C@@](CN2N=CN=C2)(C=2C(=CC(Cl)=CC=2)Cl)OC1BLSQLHNBWJLIBQ-OZXSUGGESA-N0.000description1
- LNAZSHAWQACDHT-XIYTZBAFSA-N(2r,3r,4s,5r,6s)-4,5-dimethoxy-2-(methoxymethyl)-3-[(2s,3r,4s,5r,6r)-3,4,5-trimethoxy-6-(methoxymethyl)oxan-2-yl]oxy-6-[(2r,3r,4s,5r,6r)-4,5,6-trimethoxy-2-(methoxymethyl)oxan-3-yl]oxyoxaneChemical compoundCO[C@@H]1[C@@H](OC)[C@H](OC)[C@@H](COC)O[C@H]1O[C@H]1[C@H](OC)[C@@H](OC)[C@H](O[C@H]2[C@@H]([C@@H](OC)[C@H](OC)O[C@@H]2COC)OC)O[C@@H]1COCLNAZSHAWQACDHT-XIYTZBAFSA-N0.000description1
- NWUYHJFMYQTDRP-UHFFFAOYSA-N1,2-bis(ethenyl)benzene;1-ethenyl-2-ethylbenzene;styreneChemical compoundC=CC1=CC=CC=C1.CCC1=CC=CC=C1C=C.C=CC1=CC=CC=C1C=CNWUYHJFMYQTDRP-UHFFFAOYSA-N0.000description1
- CHHHXKFHOYLYRE-UHFFFAOYSA-M2,4-Hexadienoic acid, potassium salt (1:1), (2E,4E)-Chemical compound[K+].CC=CC=CC([O-])=OCHHHXKFHOYLYRE-UHFFFAOYSA-M0.000description1
- YZEUHQHUFTYLPH-UHFFFAOYSA-N2-nitroimidazoleChemical compound[O-][N+](=O)C1=NC=CN1YZEUHQHUFTYLPH-UHFFFAOYSA-N0.000description1
- AJBZENLMTKDAEK-UHFFFAOYSA-N3a,5a,5b,8,8,11a-hexamethyl-1-prop-1-en-2-yl-1,2,3,4,5,6,7,7a,9,10,11,11b,12,13,13a,13b-hexadecahydrocyclopenta[a]chrysene-4,9-diolChemical compoundCC12CCC(O)C(C)(C)C1CCC(C1(C)CC3O)(C)C2CCC1C1C3(C)CCC1C(=C)CAJBZENLMTKDAEK-UHFFFAOYSA-N0.000description1
- WRYLYDPHFGVWKC-SNVBAGLBSA-N4-TerpineolNatural productsCC(C)[C@]1(O)CCC(C)=CC1WRYLYDPHFGVWKC-SNVBAGLBSA-N0.000description1
- 206010067484Adverse reactionDiseases0.000description1
- 244000291564Allium cepaSpecies0.000description1
- 235000002732Allium cepa var. cepaNutrition0.000description1
- 241000416162Astragalus gummiferSpecies0.000description1
- 241000193818AtopobiumSpecies0.000description1
- 240000005343Azadirachta indicaSpecies0.000description1
- 208000035143Bacterial infectionDiseases0.000description1
- 235000016068Berberis vulgarisNutrition0.000description1
- 241000335053Beta vulgarisSpecies0.000description1
- 241000186000BifidobacteriumSpecies0.000description1
- 241000901050Bifidobacterium animalis subsp. lactisSpecies0.000description1
- 241001608472Bifidobacterium longumSpecies0.000description1
- 241001474374BlenniusSpecies0.000description1
- ZOXJGFHDIHLPTG-UHFFFAOYSA-NBoronChemical compound[B]ZOXJGFHDIHLPTG-UHFFFAOYSA-N0.000description1
- 235000003880CalendulaNutrition0.000description1
- 240000001432Calendula officinalisSpecies0.000description1
- 240000003538Chamaemelum nobileSpecies0.000description1
- 235000007866Chamaemelum nobileNutrition0.000description1
- 229920002101ChitinPolymers0.000description1
- 208000035473Communicable diseaseDiseases0.000description1
- 229920001353DextrinPolymers0.000description1
- 239000004375DextrinSubstances0.000description1
- 208000004483DyspareuniaDiseases0.000description1
- 241000194031Enterococcus faeciumSpecies0.000description1
- 241001302654Escherichia coli Nissle 1917Species0.000description1
- 239000001856Ethyl celluloseSubstances0.000description1
- ZZSNKZQZMQGXPY-UHFFFAOYSA-NEthyl celluloseChemical compoundCCOCC1OC(OC)C(OCC)C(OCC)C1OC1C(O)C(O)C(OC)C(CO)O1ZZSNKZQZMQGXPY-UHFFFAOYSA-N0.000description1
- RFSUNEUAIZKAJO-ARQDHWQXSA-NFructoseChemical classOC[C@H]1O[C@](O)(CO)[C@@H](O)[C@@H]1ORFSUNEUAIZKAJO-ARQDHWQXSA-N0.000description1
- 208000031886HIV InfectionsDiseases0.000description1
- 208000037357HIV infectious diseaseDiseases0.000description1
- 241000208680Hamamelis mollisSpecies0.000description1
- 229920001479Hydroxyethyl methyl cellulosePolymers0.000description1
- 229920002153Hydroxypropyl cellulosePolymers0.000description1
- 102100035114LIM domain-binding protein 1Human genes0.000description1
- 108050000103LIM domain-binding protein 1Proteins0.000description1
- 240000001929Lactobacillus brevisSpecies0.000description1
- 235000013957Lactobacillus brevisNutrition0.000description1
- 244000199885Lactobacillus bulgaricusSpecies0.000description1
- 235000013960Lactobacillus bulgaricusNutrition0.000description1
- 241001134659Lactobacillus curvatusSpecies0.000description1
- 241000186673Lactobacillus delbrueckiiSpecies0.000description1
- 240000002605Lactobacillus helveticusSpecies0.000description1
- 235000013967Lactobacillus helveticusNutrition0.000description1
- 241000186605Lactobacillus paracaseiSpecies0.000description1
- 241000218587Lactobacillus paracasei subsp. paracaseiSpecies0.000description1
- 241000186604Lactobacillus reuteriSpecies0.000description1
- 241000917009Lactobacillus rhamnosus GGSpecies0.000description1
- 241000186612Lactobacillus sakeiSpecies0.000description1
- 244000178870Lavandula angustifoliaSpecies0.000description1
- 235000010663Lavandula angustifoliaNutrition0.000description1
- 241000124008MammaliaSpecies0.000description1
- 235000007232Matricaria chamomillaNutrition0.000description1
- WSTYNZDAOAEEKG-UHFFFAOYSA-NMayolNatural productsCC1=C(O)C(=O)C=C2C(CCC3(C4CC(C(CC4(CCC33C)C)=O)C)C)(C)C3=CC=C21WSTYNZDAOAEEKG-UHFFFAOYSA-N0.000description1
- 235000013500Melia azadirachtaNutrition0.000description1
- 241000736262MicrobiotaSpecies0.000description1
- 229920000168Microcrystalline cellulosePolymers0.000description1
- 241000699670Mus sp.Species0.000description1
- 229910004835Na2B4O7Inorganic materials0.000description1
- 240000007594Oryza sativaSpecies0.000description1
- 235000007164Oryza sativaNutrition0.000description1
- 101710121003Oxygen-evolving enhancer protein 3, chloroplasticProteins0.000description1
- 235000019482Palm oilNutrition0.000description1
- 208000029082Pelvic Inflammatory DiseaseDiseases0.000description1
- 239000002202Polyethylene glycolSubstances0.000description1
- 208000003251PruritusDiseases0.000description1
- 239000004373PullulanSubstances0.000description1
- 229920001218PullulanPolymers0.000description1
- 241000700159RattusSpecies0.000description1
- 241000283984RodentiaSpecies0.000description1
- 240000000111Saccharum officinarumSpecies0.000description1
- 235000007201Saccharum officinarumNutrition0.000description1
- 208000019802Sexually transmitted diseaseDiseases0.000description1
- 240000006474Theobroma bicolorSpecies0.000description1
- 241000218636ThujaSpecies0.000description1
- 229920001615TragacanthPolymers0.000description1
- 241001473768Ulmus rubraSpecies0.000description1
- 238000002679ablationMethods0.000description1
- DPXJVFZANSGRMM-UHFFFAOYSA-Nacetic acid;2,3,4,5,6-pentahydroxyhexanal;sodiumChemical compound[Na].CC(O)=O.OCC(O)C(O)C(O)C(O)C=ODPXJVFZANSGRMM-UHFFFAOYSA-N0.000description1
- 230000002378acidificating effectEffects0.000description1
- NIXOWILDQLNWCW-UHFFFAOYSA-Nacrylic acid groupChemical groupC(C=C)(=O)ONIXOWILDQLNWCW-UHFFFAOYSA-N0.000description1
- 150000001253acrylic acidsChemical class0.000description1
- 230000006838adverse reactionEffects0.000description1
- 238000011256aggressive treatmentMethods0.000description1
- 239000003513alkaliSubstances0.000description1
- 238000010171animal modelMethods0.000description1
- 230000002421anti-septic effectEffects0.000description1
- 238000013459approachMethods0.000description1
- 235000010323ascorbic acidNutrition0.000description1
- 239000011668ascorbic acidSubstances0.000description1
- 229960005070ascorbic acidDrugs0.000description1
- 150000003851azolesChemical class0.000description1
- 208000022362bacterial infectious diseaseDiseases0.000description1
- 244000052616bacterial pathogenSpecies0.000description1
- 239000000440bentoniteSubstances0.000description1
- 229910000278bentoniteInorganic materials0.000description1
- SVPXDRXYRYOSEX-UHFFFAOYSA-NbentoquatamChemical compoundO.O=[Si]=O.O=[Al]O[Al]=OSVPXDRXYRYOSEX-UHFFFAOYSA-N0.000description1
- 229960000686benzalkonium chlorideDrugs0.000description1
- UREZNYTWGJKWBI-UHFFFAOYSA-Mbenzethonium chlorideChemical compound[Cl-].C1=CC(C(C)(C)CC(C)(C)C)=CC=C1OCCOCC[N+](C)(C)CC1=CC=CC=C1UREZNYTWGJKWBI-UHFFFAOYSA-M0.000description1
- 229960001950benzethonium chlorideDrugs0.000description1
- CADWTSSKOVRVJC-UHFFFAOYSA-Nbenzyl(dimethyl)azanium;chlorideChemical compound[Cl-].C[NH+](C)CC1=CC=CC=C1CADWTSSKOVRVJC-UHFFFAOYSA-N0.000description1
- 229940009289bifidobacterium lactisDrugs0.000description1
- 239000011230binding agentSubstances0.000description1
- 239000000227bioadhesiveSubstances0.000description1
- 229910021538boraxInorganic materials0.000description1
- GHXRKGHKMRZBJH-UHFFFAOYSA-Nboric acidChemical compoundOB(O)O.OB(O)OGHXRKGHKMRZBJH-UHFFFAOYSA-N0.000description1
- 229910052796boronInorganic materials0.000description1
- 229960005074butoconazoleDrugs0.000description1
- SWLMUYACZKCSHZ-UHFFFAOYSA-NbutoconazoleChemical compoundC1=CC(Cl)=CC=C1CCC(SC=1C(=CC=CC=1Cl)Cl)CN1C=NC=C1SWLMUYACZKCSHZ-UHFFFAOYSA-N0.000description1
- ZHPWRQIPPNZNML-UHFFFAOYSA-Nbutoconazole nitrateChemical compoundO[N+]([O-])=O.C1=CC(Cl)=CC=C1CCC(SC=1C(=CC=CC=1Cl)Cl)CN1C=NC=C1ZHPWRQIPPNZNML-UHFFFAOYSA-N0.000description1
- 239000006227byproductSubstances0.000description1
- FUFJGUQYACFECW-UHFFFAOYSA-Lcalcium hydrogenphosphateChemical compound[Ca+2].OP([O-])([O-])=OFUFJGUQYACFECW-UHFFFAOYSA-L0.000description1
- 235000011010calcium phosphatesNutrition0.000description1
- 239000001768carboxy methyl celluloseSubstances0.000description1
- 229920002678cellulosePolymers0.000description1
- 239000001913celluloseSubstances0.000description1
- 235000010980celluloseNutrition0.000description1
- 229920003086cellulose etherPolymers0.000description1
- 239000003795chemical substances by applicationSubstances0.000description1
- 230000001684chronic effectEffects0.000description1
- 229960004022clotrimazoleDrugs0.000description1
- 235000019868cocoa butterNutrition0.000description1
- 229940110456cocoa butterDrugs0.000description1
- 150000001875compoundsChemical class0.000description1
- 238000013270controlled releaseMethods0.000description1
- 238000001816coolingMethods0.000description1
- 229920001577copolymerPolymers0.000description1
- 239000003246corticosteroidSubstances0.000description1
- 229960001334corticosteroidsDrugs0.000description1
- ZXJXZNDDNMQXFV-UHFFFAOYSA-Mcrystal violetChemical compound[Cl-].C1=CC(N(C)C)=CC=C1[C+](C=1C=CC(=CC=1)N(C)C)C1=CC=C(N(C)C)C=C1ZXJXZNDDNMQXFV-UHFFFAOYSA-M0.000description1
- 239000001939cymbopogon martini roxb. stapf. oilSubstances0.000description1
- 235000019425dextrinNutrition0.000description1
- 206010012601diabetes mellitusDiseases0.000description1
- 235000019700dicalcium phosphateNutrition0.000description1
- 235000013325dietary fiberNutrition0.000description1
- 230000029087digestionEffects0.000description1
- UQGFMSUEHSUPRD-UHFFFAOYSA-Ndisodium;3,7-dioxido-2,4,6,8,9-pentaoxa-1,3,5,7-tetraborabicyclo[3.3.1]nonaneChemical compound[Na+].[Na+].O1B([O-])OB2OB([O-])OB1O2UQGFMSUEHSUPRD-UHFFFAOYSA-N0.000description1
- CDMADVZSLOHIFP-UHFFFAOYSA-Ndisodium;3,7-dioxido-2,4,6,8,9-pentaoxa-1,3,5,7-tetraborabicyclo[3.3.1]nonane;decahydrateChemical compoundO.O.O.O.O.O.O.O.O.O.[Na+].[Na+].O1B([O-])OB2OB([O-])OB1O2CDMADVZSLOHIFP-UHFFFAOYSA-N0.000description1
- 239000000839emulsionSubstances0.000description1
- 238000005516engineering processMethods0.000description1
- 235000019325ethyl celluloseNutrition0.000description1
- 229920001249ethyl cellulosePolymers0.000description1
- 238000002474experimental methodMethods0.000description1
- 230000002349favourable effectEffects0.000description1
- 230000035558fertilityEffects0.000description1
- 239000003337fertilizerSubstances0.000description1
- 238000005429filling processMethods0.000description1
- 235000013312flourNutrition0.000description1
- 239000012530fluidSubstances0.000description1
- 239000000446fuelSubstances0.000description1
- 244000053095fungal pathogenSpecies0.000description1
- 229940029982garlic powderDrugs0.000description1
- 239000000499gelSubstances0.000description1
- 239000007903gelatin capsuleSubstances0.000description1
- 229960001235gentian violetDrugs0.000description1
- 229940107702grapefruit seed extractDrugs0.000description1
- 229940083409gyne-lotriminDrugs0.000description1
- 229940116364hard fatDrugs0.000description1
- 230000008821health effectEffects0.000description1
- 238000001794hormone therapyMethods0.000description1
- 208000033519human immunodeficiency virus infectious diseaseDiseases0.000description1
- 239000010513hydrogenated corn oilSubstances0.000description1
- 239000008172hydrogenated vegetable oilSubstances0.000description1
- 230000007062hydrolysisEffects0.000description1
- 238000006460hydrolysis reactionMethods0.000description1
- 230000002209hydrophobic effectEffects0.000description1
- 239000001863hydroxypropyl celluloseSubstances0.000description1
- 235000010977hydroxypropyl celluloseNutrition0.000description1
- 239000001866hydroxypropyl methyl celluloseSubstances0.000description1
- 235000010979hydroxypropyl methyl celluloseNutrition0.000description1
- UFVKGYZPFZQRLF-UHFFFAOYSA-Nhydroxypropyl methyl celluloseChemical compoundOC1C(O)C(OC)OC(CO)C1OC1C(O)C(O)C(OC2C(C(O)C(OC3C(C(O)C(O)C(CO)O3)O)C(CO)O2)O)C(CO)O1UFVKGYZPFZQRLF-UHFFFAOYSA-N0.000description1
- 238000001802infusionMethods0.000description1
- 239000002054inoculumSubstances0.000description1
- 238000003780insertionMethods0.000description1
- 230000037431insertionEffects0.000description1
- 239000000543intermediateSubstances0.000description1
- 239000003456ion exchange resinSubstances0.000description1
- 229920003303ion-exchange polymerPolymers0.000description1
- NLYAJNPCOHFWQQ-UHFFFAOYSA-NkaolinChemical compoundO.O.O=[Al]O[Si](=O)O[Si](=O)O[Al]=ONLYAJNPCOHFWQQ-UHFFFAOYSA-N0.000description1
- 230000002147killing effectEffects0.000description1
- 235000014655lactic acidNutrition0.000description1
- 239000004310lactic acidSubstances0.000description1
- 229940054346lactobacillus helveticusDrugs0.000description1
- 229940001882lactobacillus reuteriDrugs0.000description1
- 229940059406lactobacillus rhamnosus ggDrugs0.000description1
- 239000001102lavandula veraSubstances0.000description1
- 235000018219lavenderNutrition0.000description1
- 230000009245menopauseEffects0.000description1
- 229920000609methyl cellulosePolymers0.000description1
- 235000010270methyl p-hydroxybenzoateNutrition0.000description1
- 239000004292methyl p-hydroxybenzoateSubstances0.000description1
- 239000001923methylcelluloseSubstances0.000description1
- 235000010981methylcelluloseNutrition0.000description1
- 229960002216methylparabenDrugs0.000description1
- 229960000282metronidazoleDrugs0.000description1
- VAOCPAMSLUNLGC-UHFFFAOYSA-NmetronidazoleChemical compoundCC1=NC=C([N+]([O-])=O)N1CCOVAOCPAMSLUNLGC-UHFFFAOYSA-N0.000description1
- 229960002509miconazoleDrugs0.000description1
- 229940016286microcrystalline celluloseDrugs0.000description1
- 235000019813microcrystalline celluloseNutrition0.000description1
- 239000008108microcrystalline celluloseSubstances0.000description1
- 229940000973monistatDrugs0.000description1
- 230000017066negative regulation of growthEffects0.000description1
- 229940114496olive leaf extractDrugs0.000description1
- 230000003204osmotic effectEffects0.000description1
- 239000003346palm kernel oilSubstances0.000description1
- 235000019865palm kernel oilNutrition0.000description1
- 239000002540palm oilSubstances0.000description1
- 244000052769pathogenSpecies0.000description1
- 229920001223polyethylene glycolPolymers0.000description1
- 239000001267polyvinylpyrrolidoneSubstances0.000description1
- 229920000036polyvinylpyrrolidonePolymers0.000description1
- 235000013855polyvinylpyrrolidoneNutrition0.000description1
- 239000004302potassium sorbateSubstances0.000description1
- 235000010241potassium sorbateNutrition0.000description1
- 229940069338potassium sorbateDrugs0.000description1
- 229920001592potato starchPolymers0.000description1
- 230000035935pregnancyEffects0.000description1
- 230000008569processEffects0.000description1
- 238000012545processingMethods0.000description1
- 239000000047productSubstances0.000description1
- 235000010232propyl p-hydroxybenzoateNutrition0.000description1
- 239000004405propyl p-hydroxybenzoateSubstances0.000description1
- 229960003415propylparabenDrugs0.000description1
- 235000019423pullulanNutrition0.000description1
- 235000009566riceNutrition0.000description1
- 229940100486rice starchDrugs0.000description1
- 229960002181saccharomyces boulardiiDrugs0.000description1
- 238000007789sealingMethods0.000description1
- 235000019812sodium carboxymethyl celluloseNutrition0.000description1
- 229920001027sodium carboxymethylcellulosePolymers0.000description1
- 239000011780sodium chlorideSubstances0.000description1
- 239000004328sodium tetraborateSubstances0.000description1
- 239000012798spherical particleSubstances0.000description1
- 230000006641stabilisationEffects0.000description1
- 238000011105stabilizationMethods0.000description1
- 239000007858starting materialSubstances0.000description1
- 210000002784stomachAnatomy0.000description1
- 239000013589supplementSubstances0.000description1
- 208000011580syndromic diseaseDiseases0.000description1
- 239000011885synergistic combinationSubstances0.000description1
- 238000010189synthetic methodMethods0.000description1
- 229960000580terconazoleDrugs0.000description1
- 235000019731tricalcium phosphateNutrition0.000description1
- 229940078499tricalcium phosphateDrugs0.000description1
- 229910000391tricalcium phosphateInorganic materials0.000description1
- 208000019206urinary tract infectionDiseases0.000description1
- 235000013311vegetablesNutrition0.000description1
- 230000001018virulenceEffects0.000description1
- 229940100445wheat starchDrugs0.000description1
- 229940118846witch hazelDrugs0.000description1
- 235000013618yogurtNutrition0.000description1
Images
Classifications
- A—HUMAN NECESSITIES
- A61—MEDICAL OR VETERINARY SCIENCE; HYGIENE
- A61K—PREPARATIONS FOR MEDICAL, DENTAL OR TOILETRY PURPOSES
- A61K35/00—Medicinal preparations containing materials or reaction products thereof with undetermined constitution
- A61K35/66—Microorganisms or materials therefrom
- A61K35/74—Bacteria
- A61K35/741—Probiotics
- A61K35/744—Lactic acid bacteria, e.g. enterococci, pediococci, lactococci, streptococci or leuconostocs
- A61K35/747—Lactobacilli, e.g. L. acidophilus or L. brevis
- A—HUMAN NECESSITIES
- A61—MEDICAL OR VETERINARY SCIENCE; HYGIENE
- A61K—PREPARATIONS FOR MEDICAL, DENTAL OR TOILETRY PURPOSES
- A61K31/00—Medicinal preparations containing organic active ingredients
- A61K31/70—Carbohydrates; Sugars; Derivatives thereof
- A61K31/702—Oligosaccharides, i.e. having three to five saccharide radicals attached to each other by glycosidic linkages
- A—HUMAN NECESSITIES
- A61—MEDICAL OR VETERINARY SCIENCE; HYGIENE
- A61K—PREPARATIONS FOR MEDICAL, DENTAL OR TOILETRY PURPOSES
- A61K33/00—Medicinal preparations containing inorganic active ingredients
- A61K33/22—Boron compounds
- A—HUMAN NECESSITIES
- A61—MEDICAL OR VETERINARY SCIENCE; HYGIENE
- A61K—PREPARATIONS FOR MEDICAL, DENTAL OR TOILETRY PURPOSES
- A61K9/00—Medicinal preparations characterised by special physical form
- A61K9/0012—Galenical forms characterised by the site of application
- A61K9/0034—Urogenital system, e.g. vagina, uterus, cervix, penis, scrotum, urethra, bladder; Personal lubricants
- A—HUMAN NECESSITIES
- A61—MEDICAL OR VETERINARY SCIENCE; HYGIENE
- A61K—PREPARATIONS FOR MEDICAL, DENTAL OR TOILETRY PURPOSES
- A61K9/00—Medicinal preparations characterised by special physical form
- A61K9/02—Suppositories; Bougies; Bases therefor; Ovules
- A—HUMAN NECESSITIES
- A61—MEDICAL OR VETERINARY SCIENCE; HYGIENE
- A61K—PREPARATIONS FOR MEDICAL, DENTAL OR TOILETRY PURPOSES
- A61K9/00—Medicinal preparations characterised by special physical form
- A61K9/48—Preparations in capsules, e.g. of gelatin, of chocolate
- A—HUMAN NECESSITIES
- A61—MEDICAL OR VETERINARY SCIENCE; HYGIENE
- A61K—PREPARATIONS FOR MEDICAL, DENTAL OR TOILETRY PURPOSES
- A61K9/00—Medicinal preparations characterised by special physical form
- A61K9/48—Preparations in capsules, e.g. of gelatin, of chocolate
- A61K9/4816—Wall or shell material
- A61K9/4825—Proteins, e.g. gelatin
- A—HUMAN NECESSITIES
- A61—MEDICAL OR VETERINARY SCIENCE; HYGIENE
- A61K—PREPARATIONS FOR MEDICAL, DENTAL OR TOILETRY PURPOSES
- A61K9/00—Medicinal preparations characterised by special physical form
- A61K9/48—Preparations in capsules, e.g. of gelatin, of chocolate
- A61K9/4841—Filling excipients; Inactive ingredients
- A61K9/485—Inorganic compounds
- A—HUMAN NECESSITIES
- A61—MEDICAL OR VETERINARY SCIENCE; HYGIENE
- A61K—PREPARATIONS FOR MEDICAL, DENTAL OR TOILETRY PURPOSES
- A61K9/00—Medicinal preparations characterised by special physical form
- A61K9/48—Preparations in capsules, e.g. of gelatin, of chocolate
- A61K9/4841—Filling excipients; Inactive ingredients
- A61K9/4858—Organic compounds
- A—HUMAN NECESSITIES
- A61—MEDICAL OR VETERINARY SCIENCE; HYGIENE
- A61P—SPECIFIC THERAPEUTIC ACTIVITY OF CHEMICAL COMPOUNDS OR MEDICINAL PREPARATIONS
- A61P31/00—Antiinfectives, i.e. antibiotics, antiseptics, chemotherapeutics
- A61P31/10—Antimycotics
- A—HUMAN NECESSITIES
- A61—MEDICAL OR VETERINARY SCIENCE; HYGIENE
- A61K—PREPARATIONS FOR MEDICAL, DENTAL OR TOILETRY PURPOSES
- A61K47/00—Medicinal preparations characterised by the non-active ingredients used, e.g. carriers or inert additives; Targeting or modifying agents chemically bound to the active ingredient
- A61K47/02—Inorganic compounds
Definitions
- the present inventionrelates to a parenteral delivery device and method of delivering a multi-system treatment to a centralized location.
- the present inventionrelates to a delivery device including at least two compartments where an inner compartment encapsulates a first system and an outer compartment encapsulates a second system and the first and second systems have different mechanisms of action for use in the treatment of vaginal candidiasis and similar conditions.
- a healthy female genital tractis naturally acidic and contains beneficial bacteria that help defend against infections and maintain a normal pH level, i.e., about 3.8 to 4.5.
- Certain species of Lactobacillus genushelp maintain an optimal pH and a healthy balance of beneficial microorganisms in the vagina by excluding harmful bacteria and other pathogens present in the female genital tract, such as the small number of yeast cells, under control.
- vaginal candidiasismay be the result of an unbalanced pH that allows too many yeast cells to grow in the female genital tract.
- Most yeast infectionsare caused by a type of yeast called Candida albicans .
- Candida glabratahas also become an increasingly common cause of infection that tends to be more resistant to other treatments.
- vaginal candidiasisis chronic, returning at least 4 times a year (unrelated to antibiotic use). While vaginal candidiasis is common and causes discomfort associated with pruritus, vulvovaginal burning, and dyspareunia, such an infection is generally not serious. However, in some cases, vaginal candidiasis can leave the infected more susceptible to serious issues like fertility problems, infections, sexually transmitted diseases and pelvic inflammatory disease.
- the imbalance in pHmay be caused by a number of things including antibiotics, corticosteroids, high estrogen levels caused by pregnancy or hormone therapy, low estrogen levels caused by, for example, menopause, uncontrolled diabetes, and HIV infection.
- Over-the-counter treatmentssuch as antifungal creams and oral antifungal tablets, can kill the yeast infection and/or harmful bacteria, but do not restore the pH balance.
- These productsuse azoles and treatment can span 1 to 7 days.
- the type of azolevaries brand to brand (e.g., miconazole is used in Monistat®; clotrimazole in Gyne-Lotrimin®; butoconazole in Gynazole®).
- a terconazole creamwhich must be prescribed, is typically used to address non- albicans strains. For vaginal candidiasis requiring a more aggressive treatment than a cream, the oral antifungal fluconazole may be prescribed.
- anti-fungal medicationsmight treat the infection itself, they may also cause harm. In fact, such medications kill off both the good and bad bacteria in the female genital tract, as well as many favorable bacteria in the gut if taken orally.
- the lack of good bacteria in the female genital tractmay contribute to an increased likelihood of urinary tract infections and vaginal candidiasis. Indeed, just like some bacterial infections are resistant to antibiotics, some fungi no longer respond to the antifungal medications that are designed to cure them.
- antifungal resistance for invasive infections with the fungus CandidaSome types of Candida , e.g., Candida glabrata , are becoming resistant to fluconazole. See, e.g., Clinical Infection Diseases 1996: 22:726-7.
- tea tree oilhas been shown in several lab and animal studies to act as an antifungal against yeast. Moreover, tea tree oil contains gamma terpinene and alpha terpinene, which inhibit the growth of the fungus.
- boric acidis a natural antifungal and antiseptic, and studies have shown that it inhibits the growth of Candida albicans , as well as Candida glabrata , the use of a boric acid suppository has generally been found to be an effective over-the-counter treatment for vaginal candidiasis.
- Bacterial vaginosiswhich has similar symptoms as a yeast infection, is also caused by pathogenic bacteria in the female genital tract.
- BVis typically treated with both oral and intravaginal antibiotics, such as metronidazole and nitroimidazole, with a success rate of about 70 percent to about 80 percent within one month of treatment.
- resistance to antibiotic treatmentmay occur from G vaginalis and other anaerobes, such as Atopobium species, that aggregate in vaginal biofilms and prevent the antibiotic from reaching the organism.
- there is a high recurrence rate of BV after antibiotic treatmente.g., at least 50 percent at one year after treatment, and side effects in about 10 to 20 percent of affected individuals, including secondary vaginal infection with candida.
- vaginal candidiasis and BVthat inhibits the growth of too much yeast and/or bad bacteria in the female genital tract, but does not negatively impact healthy bacteria therein, and also promotes a healthy vaginal environment to prevent or reduce the risk of future infection.
- the present inventionis directed to a delivery device including: a first compartment including a synbiotic, wherein the synbiotic includes about 5 mg to about 150 mg by weight of a dry prebiotic and about 5 to about 500 mg by weight of a dry probiotic; a second compartment including a powder, wherein the powder includes about 60 mg to about 600 mg hydrogen borate, and wherein the second compartment is disposed about the first compartment.
- the prebioticincludes a bifidogenic oligosaccharide selected from the group consisting of fructo-oligosaccharide, galacto-oligosaccharide, inulin, isomalto-oligosaccharide, lactulose, soy-oligosaccharide, xylo-oligosaccharide, and combinations thereof.
- the delivery deviceis in the form of a suppository.
- the dry prebiotic and the dry probioticare each in the form of a powder.
- the first compartmentmay have a first diameter and the second compartment may have a second diameter, wherein the first diameter is between about 55 percent to about 80 percent of the second diameter.
- the first compartmenthas a first length and the second compartment has a second length, and wherein the first length is at between about 15 percent and 40 percent of the second length.
- the first compartment and the second compartmentare each in the form of a capsule.
- the present inventionalso relates to a vaginal delivery device including: a first capsule having a first dissolution rate and enclosing a powder, wherein the powder includes about 60 mg to about 600 mg hydrogen borate, a second capsule having a second dissolution rate and including a synbiotic powder, wherein the synbiotic powder includes about 5 mg to about 150 mg by weight of a dry prebiotic powder and about 5 mg to about 500 mg by weight of a dry probiotic powder, wherein the first capsule is disposed about the second capsule, and wherein the first dissolution rate is greater than the second dissolution rate.
- the first dissolution rateis between about 2 minutes and 15 minutes and the second dissolution rate is between about 30 minutes and about 90 minutes.
- the dry prebiotic powdermay include a short chain fructo-oligosaccharide.
- the synbioticfurther includes a preservative.
- the first capsulehas a first length and the second capsule has a second length, and wherein the second length is about 10 percent to about 40 percent less than the first length.
- the dry probiotic powdermay include Lactobacillus Iners, Lactobacillus crispatus, Lactobacillus gasseri, Lactobacillus jensenii , or combinations thereof.
- the present inventionis also directed to a method of treating or preventing vaginal candidiasis including: providing a vaginal suppository including: a first compartment including a synbiotic, wherein the synbiotic includes about 5 mg to about 150 mg by weight of a dry prebiotic and about 5 mg to about 500 mg by weight of a dry probiotic; a second compartment including a powder, wherein the powder includes about 60 mg to about 600 mg hydrogen borate, and wherein the second compartment is disposed about the first compartment; and administering the vaginal suppository to the subject.
- the administering stepfurther includes inserting the vaginal suppository into the vagina of the subject.
- the inserting stepis repeated once daily for at least three days.
- the synbioticincludes about 50 mg to about 150 mg of the prebiotic and about 40 mg to about 500 mg of the probiotic.
- the dry probioticincludes Lactobacillus Iners, Lactobacillus crispatus, Lactobacillus gasseri, Lactobacillus jensenii , or combinations thereof.
- the first compartmentmay have a first diameter and the second compartment may have a second diameter, wherein the first diameter is between about 55 percent to about 80 percent of the second diameter.
- the first compartmentmay have a first length and the second compartment may have a second length, wherein the first length is at between about 15 percent and 40 percent of the second length.
- FIG. 1is a cross-sectional view of a delivery device according to one embodiment of the invention.
- FIG. 2is a cross-sectional view of a delivery device according to another embodiment of the invention.
- FIGS. 3 A- 3 Cis a side-view of separate components of a multi-compartmented container according to one embodiment of the invention.
- FIG. 3 Dis a similar view to FIGS. 3 A- 3 C with the components assembled
- FIGS. 4 - 6are photographs of wells showing that hydrogen borate demonstrates anti- Candida albicans activity
- FIG. 7is a photograph of a well showing that hydrogen borate does not have an effect on the growth of Lactobacilli ;
- FIG. 8is a photograph of a well showing that co-cultures of C. albicans and Lactobacilli do not affect the activity of hydrogen borate.
- the present inventionis directed to a parenteral delivery device including at least two separate systems with different and distinct mechanisms of action for use in the treatment of vaginal infections such as vaginal candidiasis, bacterial vaginosis, and similar conditions.
- the present inventionfurther contemplates suitable methods to produce and use the parenteral delivery device.
- a multi-compartment delivery deviceincludes a pH modifying material in a first compartment and a synergistic combination of probiotics and prebiotics in a second compartment.
- the pH modifying materiallowers the of the female genital tract to kill the bad fungus and/or bacteria present in the female genital tract due to infection and prepares/stabilizes the biome.
- the synbioticprovides the stabilized biome an infusion of good bacteria and the fuel to allow the good bacteria to thrive and multiply in the female genital tract.
- the delivery deviceis constructed such that there are separate compartments to contain each of the systems and deliver the systems at different times. While two compartments are discussed below, it is contemplated that the delivery device of the present invention may have more than two compartments. In addition, it is also contemplated that the delivery device includes a multi-capsule system that delivers the ingredients discussed below, i.e., the pH modifying material, the probiotic, and the prebiotic, in the efficacious amounts discussed below.
- the delivery device 10includes an inner compartment 12 with contents 14 therein and an outer compartment 16 disposed about the inner compartment 12 with volume therebetween to accommodate the contents 18 of the outer compartment 16 .
- the delivery device 20includes an first compartment 22 with contents 24 therein, a second compartment 26 disposed about the first compartment 22 with volume therebetween to accommodate the contents 28 of the second compartment 26 , and a third compartment 30 disposed about the second compartment 26 with volume therebetween to accommodate the contents 32 of the third compartment 30 .
- the first and second compartmentsmay both be hard capsules each including a cap and a body where the cap has a larger external diameter than the body.
- the first (inner) and second (outer) compartmentsmay be made from a number of suitable materials including, but not limited to, hard gelatin (derived from acid-treated raw materials or alkali-treated raw materials), hydroxyl propyl methyl cellulose (HPMC), pullulan, cellulose ethers, such as starches (e.g., waxy maize starch, tapioca dextrin, corn, potato, and derivatives thereof), carrageenan, and polymers or copolymers of (meth)acrylic acids and derivatives thereof.
- suitable materialsincluding, but not limited to, hard gelatin (derived from acid-treated raw materials or alkali-treated raw materials), hydroxyl propyl methyl cellulose (HPMC), pullulan, cellulose ethers, such as starches (e.g., waxy maize starch, tapioca dextrin,
- the second (outer) compartmentis made of a material that allows for dissolution in the female genital tract within about 2 to about 15 minutes.
- the second (outer) compartmentmay be made of a material that allows for dissolution in the female genital tract within about 4 minutes to about 12 minutes.
- the second (outer) compartmentmay be made of a material that allows for dissolution in the female genital tract within about 5 minutes to about 10 minutes.
- the first (inner) compartmentis preferably made of a material that allows for delayed release of the contents contained therein such that dissolution of the first (inner) compartment occurs after the second (outer) compartment.
- the first (inner) compartmentmay be made of a material that allows for dissolution in the female genital tract within about 30 minutes to about 90 minutes of the dissolution of the second (outer) compartment.
- the first (inner) compartmentmay be formed of a material that allows dissolution of the first (inner) compartment within about 40 minutes to about 60 minutes of the dissolution of the second (outer) compartment.
- the first (inner) compartmentmay be made of a material that allows for dissolution in the female genital tract within about 45 minutes to about 55 minutes.
- the first (inner) compartmentis a HPMC capsule and the second (outer) compartment is a plant, gelatin, or VCAP low moisture capsule.
- plant-based capsules for the second (outer) compartmentinclude, but are not limited to, starch (e.g., from potato, tapioca, or corn) and carrageenan (from seaweed).
- the first (inner) compartmentis a HPMC capsule that has a disintegration rate of at least about 45 minutes and the second (outer) compartment is a plant, gelatin, or VCAP low moisture capsule.
- the first (inner) compartmentmay have a disintegration rate of about 50 minutes or greater.
- the first and second compartmentsmay each contain a liquid, a semi-solid formulation (e.g., a slurry), powder, or pellets.
- the first and second compartmentsmay each contain a powder.
- delayed release of the contents of the first (inner) compartmentmay be accomplished through osmotic controlled release.
- the first (inner) compartmentmay be a rigid tablet and the second (outer) compartment is a plant, gelatin, or VCAP low moisture capsule.
- the first and second compartmentsmay each contain a liquid, a semi-solid formulation (e.g., a slurry), powder, or pellets.
- the delayed release of the contents of the first (inner) compartmentis achieved via microencapsulation, lipid microparticle coating, acrylic coating, chitin coating, gel forming delivery matrices, polymer coatings, ion exchange resin coatings, bio-adhesive mucous bonding coatings, hydrophobic matrices, lipid matrices, hydrophilic matrices, biodegradable matrices, mineral matrices, and combinations thereof.
- the delayed release of the contents of the first (inner) compartmentmay be the result of lipid microparticle coating rather than the material used to form the first (inner) compartment.
- the liquid, semi-solid, powder, or pellets included in the first (inner) compartmentmay be embedded within lipid multiparticulates (LMPs).
- LMPsmay be spherical particles having a size ranging from about 50 ⁇ m to about 300 ⁇ m.
- the liquid, semi-solid, powder, or pelletsmay be coated with the LMPs using a fluidized bed process.
- at least some of the liquid, semi-solid, powder, or pellets included in the first (inner) compartmentmay be present in an LMP matrix.
- amphiphilic excipientsmay also be used.
- solid lipid pelletsmay be formed by injecting a lipid matrix composed of a hard fat and a glycerol ester into the liquid, semi-solid, powder, or pellets that is intended to be used in the first (inner) compartment. Upon cooling, solid lipid pellets are formed and loaded into the first (inner) compartment.
- the first (inner) compartmentmay be a hard capsule and the outer compartment may be a soft capsule.
- the hard capsule that forms the first (inner) compartmentmay be formed from any of the materials noted above and the second (outer) compartment may be made from soft gelatin, agar, or the like.
- the hard and soft capsulesmay each contain a liquid, a semi-solid formulation (e.g., a slurry), powder, or pellets.
- the first (inner) compartmentis smaller than the second (outer) compartment in terms of empty volume capacity, empty overall closed length, or external diameter so that the second (outer) compartment may be disposed about the inner compartment.
- the empty volume capacity (ml) of the first (inner) compartmentis between about 20 percent and 60 percent of the empty volume capacity of the second (outer) compartment.
- the empty volume capacity (ml) of the first (inner) compartmentmay be between about 25 percent and 60 percent of the empty volume capacity of the second (outer) compartment.
- the empty volume capacity (ml) of the first (inner) compartmentis between about 30 percent and 40 percent of the empty volume capacity of the second (outer) compartment.
- the first (inner) compartmenthas an empty capsule volume capacity of about 0.27 ml to about 0.78 ml and the second (outer) compartment has an empty volume capacity of about 0.78 ml to about 1.37 ml.
- the first (inner) compartmenthas an empty capsule volume capacity of about 0.36 ml to about 0.78 ml and the second (outer) compartment has an empty volume capacity of about 0.9 ml to about 1.37 ml.
- the first (inner) compartmenthas an empty capsule volume capacity of about 0.48 ml to about 0.68 ml and the second (outer) compartment has an empty volume capacity of about 1.00 ml to about 1.37 ml.
- the overall closed length of the first (inner) compartmentis less than the overall closed length of the second (outer) compartment. In one embodiment, the overall closed length of the first (inner) compartment is about 10 percent to about 40 percent less than the overall closed length of the second (outer) compartment. In another embodiment, the overall closed length of the first (inner) compartment is about 15 percent to about 35 percent less than the overall closed length of the second (outer) compartment. In yet another embodiment, the overall closed length of the first (inner) compartment is about 18 percent to about 25 percent less than the overall closed length of the second (outer) compartment.
- the overall closed length of the first (inner) compartmentmay range from about 0.618 inches to about 0.909 inches. In one embodiment, the first compartment has an overall closed length of about 0.693 inches to about 0.85 inches. In another embodiment, the first (inner) compartment has an overall closed length of about 0.764 inches to about 0.85 inches.
- the overall closed length of the second (outer) compartmentmay range from about 0.909 inches to about 1.029 inches. In one embodiment, the second (outer) compartment has an overall closed length of about 0.921 inches to about 1.029 inches. In another embodiment, the second (outer) compartment has an overall closed length of about 0.996 inches to about 1.029 inches.
- the external diameter of the second (outer) compartmentis larger than the external diameter of the first (inner) compartment.
- the external diameter of the first (inner) compartmentis about 55 percent to about 80 percent of the external diameter of the second (outer) compartment.
- the external diameter of the first (inner) compartmentis about 60 percent to about 78 percent of the external diameter of the second (outer) compartment.
- the external diameter of the first (inner) compartmentis about 70 percent to about 77 percent of the external diameter of the second (outer) compartment.
- the capWhen both of the first (inner) and second (outer) compartments are hard capsules including a cap and a body, the cap has a larger external diameter than the body.
- the first (inner) compartmentmay include a cap with an empty external diameter that ranges from about 0.230 inches to about 0.301 inches for the cap and a body with an empty external diameter that ranges from about 0.220 inches to about 0.289 inches.
- the first (inner) compartmentmay include a cap with an empty external diameter that ranges from about 0.252 inches to about 0.301 inches for the cap and a body with an empty external diameter that ranges from about 0.240 inches to about 0.289 inches.
- the first (inner) compartmentmay include a cap with an empty external diameter that ranges from about 0.274 inches to about 0.301 inches for the cap and a body with an empty external diameter that ranges from about 0.260 inches to about 0.289 inches.
- the second (outer) compartmentmay include a cap with an empty external diameter that ranges from about 0.301 inches to about 0.390 inches for the cap and a body with an empty external diameter that ranges from about 0.289 inches to about 0.375 inches.
- the second (outer) compartmentmay include a cap with an empty external diameter that ranges from about 0.337 inches to about 0.390 inches for the cap and a body with an empty external diameter that ranges from about 0.322 inches to about 0.375 inches.
- the first (inner) compartmentmay include a cap with an empty external diameter that ranges from about 0.338 inches to about 0.375 inches for the cap and a body with an empty external diameter that ranges from about 0.324 inches to about 0.375 inches.
- the first (inner) compartmentmay range from a size 3 capsule to a size 0E capsule.
- the second (outer) compartmentmay range from a size 0E capsule to a size 000 capsule.
- the first (inner) compartmentis a size 0 capsule and the second (outer) compartment is a size 000 capsule.
- the first (inner) compartmentis a size 3 capsule and the second (outer) compartment is a size 0E capsule.
- the first (inner) compartmentis a size 2 capsule and the second (outer) compartment is a size 00 capsule.
- the first (inner) compartmentis a size 1 capsule and the second (outer) compartment is a size 00E capsule.
- the first (inner) compartmentis a size 0E capsule and the second (outer) compartment is a size 000 capsule.
- the delivery deviceis a multi-compartmented container where each compartment is distinct and separate, but not necessarily constructed such that is has an outer compartment fully disposed about and enclosing the inner compartment. Rather, in this aspect of the invention, the delivery device is a multi-compartmented container including a body, a first cap, and a second cap where the body and the top cap form a first compartment and the bottom cap attaches to a closed end of the first compartment to form the second compartment.
- the containerincludes a body 42 , a first cap 44 , and a second cap 46 such that two distinctly separate compartments are formed and are able to contain different contents.
- the body 40 and the first cap 42When assembled, the body 40 and the first cap 42 constitute a first compartment 48 .
- a second compartment 50is formed.
- the components 42 , 44 , and 46are designed so that the first cap 44 and the second cap 46 can be telescopically fitted onto the body 42 , i.e., the first and second caps can be coaxially and slideably mounted on the outer surface of the body 42 .
- the body 42includes a pair of annular grooves 42 a , 42 b near its open end 42 d so that a corresponding inwardly-projecting annular ridge 44 a of first cap 44 may alternately engage when open end 44 b of first cap 44 is slideably mounted on the outer surface of the body 42 .
- annular ridge 44 aengages first annular groove 42 a , forming a pre-fill position that allows first cap 44 to be removed from the body 42 for filling.
- first cap 44 and body 42are placed in a lock position, wherein annular ridge 44 a engages annular groove 42 b .
- the disengagement axial force of first cap 44 from body 42 in the pre-fill positionis less than the disengagement force of first cap from body 42 in the lock position.
- the body 42 and the first cap 44may be sealed with a sealing fluid, heat, or some other mechanism.
- a second compartment 50is formed when the open end 46 b of second cap 46 is slideably mounted on the closed end 42 e of body 42 .
- the body 42includes a third annular groove 42 c near its closed end 42 e that may be engaged by an inwardly-projecting annular ridge 46 a of second cap 46 .
- the body 42may include a pair of annular grooves near its closed end 42 e so that the second compartment may be formed with pre-fill and lock positions similar to the first compartment.
- the second compartmentmay be filled with second contents 50 a.
- body 42 , first cap 44 , and second cap 46are formed of the same materials.
- body 42 and first cap 44are formed of the same material having a first dissolution or disintegration rate and second cap 46 is formed of a different material having a second dissolution or disintegration rate that is slower than the first dissolution or disintegration rate.
- the contents 50 a contained in the second compartment 50will be released after the first contents 48 a in the first compartment 48 .
- such a delivery deviceis beneficial because the first contents 48 a kill the bad bacteria present in the biome and stabilize the biome prior to introduction of the second contents 50 a.
- body 42 and first cap 44are formed of the same material having a first dissolution or disintegration rate and second cap 46 is formed of a different material having a second dissolution or disintegration rate that is greater than the first dissolution or disintegration rate.
- first dissolution or disintegration ratethe contents 50 a contained in the second compartment 50 will be released before the first contents 48 a in the first compartment 48 .
- such a delivery deviceis beneficial because the contents 50 a kill the bad bacteria present in the biome and stabilize the biome prior to introduction of the first contents 48 a .
- U.S. Pat. Nos. 8,968,717 and 9,456,990disclose other embodiments of a multi-compartmented container suitable for use with the present invention.
- the first compartmenti.e., the body 42 and first cap 44
- the length of the first compartmentmay range from about 0.3 inches to about 1.0 inch. In one embodiment, the length of the first compartment ranges from about 0.4 inches to about 0.9 inches. In another embodiment, the length of the first compartment ranges from about 0.5 inches to about 0.8 inches.
- the multi-compartmented container 40may have a length that ranges from about 0.75 inches to about 1.1 inches. In another embodiment, the multi-compartmented container 40 may have a length that ranges from about 0.8 inches to about 1.0 inch. In yet another embodiment, the length of the multi-compartmented container 40 ranges from about 0.85 inches to about 0.95 inches.
- the diameter of the multi-compartmented container 40ranges from about 0.2 inches to about 0.4 inches. In one embodiment, the container 40 has a diameter that ranges from about 0.22 inches to about 0.38 inches. In another embodiment, the container 40 has a diameter that ranges from about 0.24 inches to about 0.38 inches.
- the disclosed delivery deviceincludes a pH modifying material in at least one of the compartments, for example, the second (outer) compartment.
- pH modifying materialrefers to any material capable of altering the pH of the female genital tract, for example, lowering the pH of the female genital tract.
- the pH modifying materialmay also be effective for killing off harmful bacteria and fungus present in the female genital tract.
- the pH modifying materialmay have a pH that ranges from about 8 to 10 in pure water at 25° C. and 1 atm.
- the pH modifying materialmay include lactic acid, ascorbic acid, hydrogen borate (also referred to as boric acid), or combinations thereof.
- the pH modifying materialis hydrogen borate.
- the pH modifying materialmay be formulated as a solid.
- the pH modifying materialmay be formulated as a powder, pellet, or granule.
- the pH modifying materialmay be formulated as a liquid or a semi-solid formulation.
- the pH modifying materialmay be formulated as a slurry or an emulsion.
- the pH modifying materialis formulated as a powder.
- the pH modifying materialmay include hydrogen borate in powder form.
- the pH modifying materialmay be used in an amount of about 50 mg to about 600 mg.
- the pH modifying materialmay be used in an amount of about 60 mg to about 600 mg.
- the pH modifying materialmay be used in an amount of about 100 mg to about 550 mg.
- the pH modifying materialmay be used in an amount of about 200 mg to about 500 mg.
- the pH modifying materialmay be used in an amount of about 250 mg to about 400 mg.
- the pH modifying materialmay be used in an amount of about 275 mg to about 325 mg.
- the pH modifying materialmay be used in an amount of about 300 mg.
- the pH modifying materialis formulated in a pH modifying slurry.
- the pH modifying slurryincludes the at least one pH modifying material in an oil medium with antifungal properties.
- the oil mediummay be tea tree oil, coconut oil, oregano oil, grape seed oil, lemon oil, peppermint oil, cinnamon oil, or the like, or combinations thereof.
- the oil mediumis a tea tree oil prepared as a terpinen-4-ol type. In fact, the minimization of 1,8-cineole content in the tea tree oil is preferable to minimize adverse reactions.
- the oil mediumis a coconut oil.
- the oil mediumis a blend of tea tree oil and coconut oil.
- the oil mediumis a blend of at least three of the following: tea tree oil, coconut oil, oregano oil, grape seed oil, lemon oil, peppermint oil, and cinnamon oil.
- the oil mediummay be included in the pH modifying slurry in an amount ranging from about 150 mg to about 1200 mg.
- the pH modifying slurrymay include about 180 mg to about 1100 mg of oil medium in the pH modifying slurry.
- the oil mediummay be included in the pH modifying slurry in an amount of about 720 mg to about 850 mg.
- the pH modifying slurrymay include about 740 mg to about 825 mg of oil medium in the pH modifying slurry.
- the pH modifying slurrymay include about 750 mg to about 780 mg of oil medium in the pH modifying slurry.
- the pH modifying slurrymay include about 950 mg to about 1200 mg of oil medium in the pH modifying slurry.
- the oil mediummay be included in the pH modifying slurry in an amount of about 1000 mg to about 1150 mg.
- the pH modifying slurrymay include about 1020 mg to about 1120 mg of oil medium in the pH modifying slurry.
- the pH modifying slurryincludes about 1050 mg to about 1100 mg of oil medium in the pH modifying slurry.
- the pH modifying slurrymay include about 150 mg to about 580 mg of oil medium in the pH modifying slurry. In yet another embodiment, the pH modifying slurry may include about 180 mg to about 550 mg of oil medium in the pH modifying slurry. For example, when the outer capsule is a size 00 capsule, the pH modifying slurry may include about 450 mg to about 480 mg of oil medium in the pH modifying slurry.
- the pH modifying slurrymay include about 450 mg to about 900 mg of oil medium in the pH modifying slurry.
- the oil mediummay be included in the pH modifying slurry in an amount of about 500 mg to about 850 mg.
- the pH modifying slurrymay include about 750 mg to about 800 mg of oil medium in the pH modifying slurry.
- the oil mediummay include up to about 45 percent solid materials. In one embodiment, the oil medium includes up to about 30 percent solid materials. In another embodiment, the oil medium includes up to about 20 percent solid materials. In yet another embodiment, the oil medium includes up to about 10 percent solid materials. In still another embodiment, the oil medium includes less than 1 percent solid materials. For example, the oil medium may include less than 0.05 percent solid materials.
- the pH modifying slurrymay include about 50 mg to about 600 mg of the pH modifying material. In one embodiment, the pH modifying slurry includes about 60 mg to about 550 mg of the pH modifying material. In another embodiment, the pH modifying slurry includes about 200 mg to about 500 mg of the pH modifying material. In still another embodiment, the pH modifying slurry includes about 250 mg to about 400 mg of the pH modifying material. In another embodiment, the pH modifying slurry includes about 275 mg to about 325 mg of pH modifying material. For example, the pH modifying material may be included in the pH modifying slurry in an amount of about 300 mg.
- the pH modifying slurrymay include about 18 percent to about 55 percent of the pH modifying material by weight of the pH modifying slurry. In another embodiment, the pH modifying slurry may include about 23 percent to about 53 percent of the pH modifying material by weight of the modifying slurry. In another embodiment, the pH modifying slurry may include about 25 percent to about 45 percent of the pH modifying material by weight of the pH modifying slurry. In still another embodiment, the pH modifying slurry may include about 27 percent to about 40 percent of the pH modifying material by weight of the pH modifying slurry. In yet another embodiment, the pH modifying material is included in an amount of about 30 percent to about 38 percent by weight of the pH modifying slurry.
- the pH modifying slurryincludes about 38 percent to about 40 percent of the pH modifying material by weight of the pH modifying slurry.
- the pH modifying slurrymay include about 27 percent to about 29 percent of the pH modifying material by weight of the pH modifying slurry.
- the pH modifying slurrymay contain slippery elm powder, garlic powder, calendula, olive leaf extract, gentian violet, grapefruit seed extract, witch hazel, palmarosa oil, onion powder, neem, harad herb, thuja, lavender, chamomile, and combinations thereof.
- the pH modifying slurrymay contain suitable excipients and auxiliaries that facilitate processing of the slurry.
- suitable excipientsinclude tillers such as calcium phosphates (e.g., tricalcium phosphate or calcium hydrogen phosphate) and binders such as starch, paste, using, for example, maize starch, wheat starch, rice starch, potato starch, gelatin, gum tragacanth, vegetable cellulose such as methyl cellulose, ethyl cellulose, hydroxypropyl cellulose, hydroxypropylmethyl cellulose sodium carboxymethylcellulose, and hydroxyethyl methyl cellulose, and/or polyvinyl pyrrolidone.
- tillerssuch as calcium phosphates (e.g., tricalcium phosphate or calcium hydrogen phosphate)
- binderssuch as starch, paste, using, for example, maize starch, wheat starch, rice starch, potato starch, gelatin, gum tragacanth, vegetable cellulose such as methyl
- the synbioticis a blend of at least one probiotic and at least one prebiotic.
- the probiotic and prebioticmay be formulated as a solid.
- the probiotic and prebioticmay be formulated as a powder, pellet, or granule.
- the probiotic and the prebioticare formulated as powders.
- the synbioticincludes about 5 mg to about 600 mg of probiotics and about 5 mg to about 200 mg of prebiotics. In another embodiment, the synbiotic includes about 5 mg to about 500 mg of probiotics and about 5 mg to about 150 mg of prebiotics. In still another embodiment, the synbiotic includes about 25 mg to about 500 mg of probiotics and about 25 mg to about 150 mg of prebiotics. In another embodiment, the synbiotic includes about 40 mg to about 500 mg of probiotics and about 50 mg to about 150 mg of prebiotics. In still another embodiment, the synbiotic includes about 100 mg, to about 450 mg of probiotics and about 75 mg to about 125 mg of prebiotics. In yet another embodiment, the synbiotic includes about 400 mg of probiotics and 100 mg of prebiotics.
- Suitable probiotics for use in the synbioticare any number of defined viable microorganisms that reach the female genital tract in an active state and thus exert positive health effects.
- a species of Lactobacillusis employed as the probiotic portion of the synbiotic blend.
- Lactobacillus inersLactobacillus crispatus, Lactobacillus gasseri, Lactobacillus jensenii, Lactobacillus rhamnosus GG, Lactobacillus reuteri (RC-14), Lactobacillus acidophilus, Lactobacillus delbrueckii, Lactobacillus helveticus, Lactobacillus salivarius, Lactobacillus casei, Lactobacillus paracasei, Lactobacillus curvatus, Lactobacillus plantarum, Lactobacillus sakei, Lactobacillus brevis, Lactobacillus buchneri, Lactobacillus fermentum, Bifidobacterium lactis, B.
- the probioticincludes at least one of Lactobacillus iners, Lactobacillus crispatus, Lactobacillus gasseri, Lactobacillus jensenii , or combinations thereof.
- the probioticincludes at least one of Lactobacillus acidophilus LA02, Lactobacillus buchneri Lb26, Lactobacillus fermentum ME-3, Lactobacillus salivarius subsp. salivarius CRL 1328, Lactobacillus crispatus CRL 1266, Lactobacillus paracasei subsp.
- the probiotic employedincludes Bifidobacterium and certain strains of Lactobacillus casei or the Lactobacillus acidophilus -group. In yet another embodiment, the probiotic employed includes any of the above species of Lactobacillus and Escherichia coli strain Nissle 1917, Enterococcus faecium SF68, the probiotic yeast Saccharomyces boulardii , or combinations thereof.
- Prebioticsdiffer from probiotics in that they act as a fertilizer for the good bacteria that is already present in the body.
- probioticsare live bacteria that are susceptible to heat, acid, and time
- prebioticsare indigestible dietary fibers that are not destroyed in the body because they are not susceptible to heat, cold, acid, or time.
- Suitable prebiotics for use in the synbioticare any number of selectively fermented ingredients that allows specific changes, both in the composition and/or activity in the female genital tract.
- the prebioticincludes short chain fructo-oligosaccharides (scFOS).
- the scFOSmay be derived from beet or sugar cane.
- the synbioticincludes about 25 mg to about 200 mg of scFOS and about 25 mg to about 600 mg of Lactobacilli . In another embodiment, the synbiotic includes about 50 mg to about 175 mg of scFOS and about 40 mg to about 500 mg of Lactobacilli . In still another embodiment, the symbiotic includes about 80 mg to about 140 mg of scFOS and about 75 mg to about 400 mg of Lactobacilli.
- the synbioticincludes an excipient such as rice flour.
- the synbioticincludes a flow agent such as silicon dioxide or microcrystalline cellulose to aid the powder in flowing into the capsules during the filling process.
- the synbioticmay also be suspended in a base.
- the basemay be polyethylene glycol, hydrogenated vegetable oils, cocoa butter, Theobroma oil, hydrogenated corn oil, palm oil, palm kernel oil, coconut oil, or combinations thereof. When a base is present, it may be used in an amount of about 50 percent to about 90 percent by weight of the synbiotic.
- the synbioticmay also include a preservative, a suspending agent (when a base is used), or both.
- Suitable preservativesinclude, but are not limited to, methylparaben, propylparaben, potassium sorbate, benzalkonium chloride, benzethonium chloride, and combinations thereof. When used, the preservative may be present in an amount of about 0.1 percent to about 0.2 percent by weight of the synbiotic.
- Suitable suspending agentsinclude, but are not limited to, silicon dioxide, bentonite, hydrated aluminum silicate, and mixtures thereof. When used, the suspending agent may be present in an amount of about 0.1 percent to about 2.0 percent by weight.
- the pH modifying materialis hydrogen borate
- the hydrogen boratemay be prepared by reacting borax (sodium tetraborate decahydrate) with a mineral acid, such as hydrochloric acid: Na 2 B 4 O 7 ⁇ 10H 2 O+2 HCl ⁇ 4 B(OH) 3 [or H 3 BO 3 ]+2 NaCl+5 H 2 O
- the crystalline pH modifying materialmay be mixed with an oil medium or base to create the pH modifying slurry.
- about 4 to about 15 percent of the pH modifying material based on total volume of the pH modifying slurryis added to the oil medium.
- about 5 to about 12 percent of the pH modifying material based on total volume of the pH modifying slurryis added to the oil medium.
- about 8 to about 10 percent of the pH modifying material based on total volume of the pH modifying slurryis added to the oil medium.
- the oil mediumis present in the pH modifying slurry in an amount of about 85 percent to about 96 percent based on the total volume of the pH modifying slurry.
- the oil mediumis present in the pH modifying slurry in an amount of about 88 percent to about 95 percent based on the total volume of the pH modifying slurry. In another embodiment, about 90 percent to about 92 percent of the oil medium is present in the pH modifying slurry based on the total volume of the pH modifying slurry.
- Each compartment of the delivery devicemay be filled using standard capsule-filling technology, such as intermittent or continuous motion capsule filling machines equipped with dosators.
- the outer compartmentis filled and then the cap of the outer compartment is secured to form the delivery device of the present invention.
- the second compartmentis filled and securely attached to the first compartment.
- the delivery devicecan be used, for example, to treat or prevent vaginal infections such as vaginal candidiasis, bacterial vaginosis, and similar conditions.
- Treat,” “treating,” and “treatment” as used hereinrefer to alleviating, reducing, or inhibiting one or more symptoms or physiological aspects of a disease, disorder, syndrome, or condition.
- Treatmentcovers any treatment of a disease in a subject, and includes: (a) preventing the disease or symptom from occurring in a subject which may be predisposed to the disease or symptom, but has not yet been diagnosed as having it; (b) inhibiting the disease or symptom, i.e., arresting or preventing its development; (c) reducing the severity of the disease or symptom; or (d) relieving the disease symptom, i.e., causing regression of the disease or symptom.
- preventrefers to administering a composition to a subject at risk for or having a predisposition for one or more symptoms caused by a disease or disorder to cause cessation of a particular symptom of the disease or disorder, a reduction or prevention of one or more symptoms of the disease or disorder, a reduction in the severity of the disease or disorder, the complete ablation of the disease or disorder, or stabilization or delay of the development or progression of the disease or disorder.
- the delivery devicecan be formulated for administration by parenteral or transmucosal routes of administration.
- the delivery devicemay be formulated as a vaginal suppository.
- the present disclosureprovides for a method of treatment and/or prevention of a vaginal infection, such as vaginal candidiasis, bacterial vaginosis, and similar conditions, in a subject in need thereof, the method including administering the delivery device to the subject.
- a vaginal infectionsuch as vaginal candidiasis, bacterial vaginosis, and similar conditions
- the term “subject” as used hereinrefers to a mammal, including, but not limited to, humans, rodents, such as mice and rats, and other laboratory animals.
- the delivery devicemay be administered to the subject by inserting the delivery device into the vagina of the subject. If, after the administration of the delivery device, the subject is still infected with vaginal candidiasis and/or bacterial vaginosis, then an optional step of the method is to continue administration of the delivery device.
- An effective treatmentmay range from about 3-7 delivery devices over a 7-day period.
- two delivery devicesare inserted in the female genital tract (optionally at bedtime) for seven continuous days.
- the delivery deviceincludes about 200 mg to about 400 mg of the pH modifying material
- two delivery devices per daymay be used.
- one delivery deviceis inserted in the female genital tract (optionally at bedtime) for seven continuous days.
- the delivery deviceincludes more than about 400 mg and up to about 600 mg of the pH modifying material, one delivery device per day may be used.
- the treatment aboveis used for two weeks, and then the delivery device may be used twice a week for six months to one year.
- the inner (or second) compartmentstarts to dissolve and the contents are delivered to the female genital tract.
- the multi-compartment delivery deviceallows for the different systems to be separated until such times as they are released.
- the disclosed delivery devicecan be administered to a subject in need thereof in combination or alternation with other therapies and therapeutic agents.
- the disclosed delivery device and the additional therapeutic agentare administered separately, but simultaneously, or in alternation.
- the additional therapeutic agentcan also be administered as part of the disclosed delivery device.
- a delivery device with a size 0 inner capsule and a size 000 outer capsuleThe inner capsule is a HPMC capsule filled with a powder blend of 100 mg powdered scFOS and 150 mg of Lactobacillus Iners, 125 mg of Lactobacillus crispatus, 75 mg Lactobacillus gasseri , and 50 mg of Lactobacillus jensenii .
- the inner capsuleis placed inside the body of the outer capsule and then filled with 600 mg of pH modifying slurry before securing the cap of the outer capsule.
- the pH modifying slurryincludes 300 mg of hydrogen borate and 300 mg of tea tree oil.
- the outer capsuleis a gelatin capsule.
- Candida albicansATTC number 10231, was used as a test organism. Cultures of C. albicans were grown in a rotator overnight at room temperature in tubes of LB-broth. The cultures contained approximately 1 ⁇ 10 8 organisms per mL. The suspension was diluted 1:1000 in LB-broth and 50 microliters were spread on the surface of a LB-agar plate, i.e., approximately 5,000 organisms.
- a wellwas punched into the agar following the application of C. albicans and 60 mg of the hydrogen borate (boric acid) was added to the well followed by 25 microliters of water. Plates were incubated at 37 degrees centigrade overnight and observed for growth and/or a zone of inhibition (clear area) around the well containing the hydrogen borate.
- the hydrogen borateboric acid
- FIGS. 4 - 6show that the hydrogen borate (60 mg) generated a zone of inhibition (represented by the clear area) against the yeast, Candida albicans .
- the hydrogen borategenerated a 45 mm zone of inhibition against the yeast, Candida albicans.
- Lactobacillus capsular material(40 mg) was suspended in 1.0 milliliter of LB-broth and 25 microliters was spread on the surface of half of an LB-agar plate. For comparison, the other half of the plate spread with C. albicans . A hole was punched in the middle of the plate and 60 mg of hydrogen borate was added. The plates were incubated overnight and scored for growth and/or a zone of inhibition around the hydrogen borate well.
- the C. albicanswas co-cultured with the Lactobacilli .
- equal volumes of the two suspensions of organisms described earlierwere mixed and used to spread on LB-agar plates for testing for any effect of the co-culture on the anti-yeast activity of hydrogen borate or any effect on Lactobacillus growth.
- the hydrogen boratedid not have an effect on the growth of Lactobacilli . Regardless of whether the Lactobacilli was added to the kill zones one hour or 12 hours after the hydrogen borate was put in the wells, there was no demonstrable effect on the growth of the Lactobacilli.
- FIG. 8shows a co-culture of C. albicans and Lactobacilli where Lactobacilli was added dropwise immediately after C. albicans was spread onto the plate.
- co-cultures of C. albicans and Lactobacillidid not affect the activity of the hydrogen borate.
- the positive anti-yeast activityremained active and there was a lack of activity against Lactobacilli .
- the co-culture experimentalso showed that the growth of the two organisms do not appear to affect each other.
- a multi-capsule delivery systemincluding one capsule including the pH modifying slurry, one capsule containing the probiotic, and one capsule containing the prebiotic in the amounts described above.
- the capsule containing the pH modifying slurrymay be inserted at the same time as the capsule containing the synbiotic or, if separate, capsules containing the probiotic and prebiotic.
- the capsule containing the pH modifying slurrymay be first inserted and then, after predetermined period of time, the capsule containing the synbiotic or, if separate, capsules containing the probiotic and prebiotic may be inserted.
- the predetermined period of time before the insertion of the capsule containing the synbiotic or, if separate, capsules containing the probiotic and prebioticis between about 30 minutes and 2 hours, preferably about 45 minutes to about 75 minutes, and more preferably about 55 minutes to about 65 minutes.
- Such modificationsare also intended to fall within the scope of the appended claims. All patents and patent applications cited in the foregoing text are expressly incorporate herein by reference in their entirety.
Landscapes
- Health & Medical Sciences (AREA)
- Life Sciences & Earth Sciences (AREA)
- Chemical & Material Sciences (AREA)
- Animal Behavior & Ethology (AREA)
- Pharmacology & Pharmacy (AREA)
- General Health & Medical Sciences (AREA)
- Public Health (AREA)
- Veterinary Medicine (AREA)
- Medicinal Chemistry (AREA)
- Epidemiology (AREA)
- Inorganic Chemistry (AREA)
- Molecular Biology (AREA)
- Mycology (AREA)
- Microbiology (AREA)
- Reproductive Health (AREA)
- Oncology (AREA)
- Chemical Kinetics & Catalysis (AREA)
- General Chemical & Material Sciences (AREA)
- Nuclear Medicine, Radiotherapy & Molecular Imaging (AREA)
- Organic Chemistry (AREA)
- Communicable Diseases (AREA)
- Urology & Nephrology (AREA)
- Gynecology & Obstetrics (AREA)
- Medicinal Preparation (AREA)
Abstract
Description
Na2B4O7·10H2O+2 HCl→4 B(OH)3[or H3BO3]+2 NaCl+5 H2O
B2H6+6 H2O→2 B(OH)3+6 H2
BX3+3 H2O→B(OH)3+3 HX
where X may be Cl, Br, I.
Claims (18)
Priority Applications (2)
| Application Number | Priority Date | Filing Date | Title |
|---|---|---|---|
| US15/987,729US12011469B2 (en) | 2017-05-23 | 2018-05-23 | Parenteral delivery device and methods of use |
| US18/741,897US20240325470A1 (en) | 2017-05-23 | 2024-06-13 | Parenteral delivery device and methods of use |
Applications Claiming Priority (2)
| Application Number | Priority Date | Filing Date | Title |
|---|---|---|---|
| US201762509841P | 2017-05-23 | 2017-05-23 | |
| US15/987,729US12011469B2 (en) | 2017-05-23 | 2018-05-23 | Parenteral delivery device and methods of use |
Related Child Applications (1)
| Application Number | Title | Priority Date | Filing Date |
|---|---|---|---|
| US18/741,897ContinuationUS20240325470A1 (en) | 2017-05-23 | 2024-06-13 | Parenteral delivery device and methods of use |
Publications (2)
| Publication Number | Publication Date |
|---|---|
| US20180339003A1 US20180339003A1 (en) | 2018-11-29 |
| US12011469B2true US12011469B2 (en) | 2024-06-18 |
Family
ID=64400195
Family Applications (2)
| Application Number | Title | Priority Date | Filing Date |
|---|---|---|---|
| US15/987,729ActiveUS12011469B2 (en) | 2017-05-23 | 2018-05-23 | Parenteral delivery device and methods of use |
| US18/741,897PendingUS20240325470A1 (en) | 2017-05-23 | 2024-06-13 | Parenteral delivery device and methods of use |
Family Applications After (1)
| Application Number | Title | Priority Date | Filing Date |
|---|---|---|---|
| US18/741,897PendingUS20240325470A1 (en) | 2017-05-23 | 2024-06-13 | Parenteral delivery device and methods of use |
Country Status (1)
| Country | Link |
|---|---|
| US (2) | US12011469B2 (en) |
Citations (10)
| Publication number | Priority date | Publication date | Assignee | Title |
|---|---|---|---|---|
| WO2003080813A2 (en)* | 2002-03-21 | 2003-10-02 | Bifodan A/S | Lactobacillus strains |
| US20050053648A1 (en)* | 2003-09-08 | 2005-03-10 | Chalmers Anne Marie | Medication delivery device |
| US20080193428A1 (en)* | 2005-04-27 | 2008-08-14 | Shenzhen Phlora Biotechnology Limited | Composition and Method for Modulating and Maintaining Vaginal Bacterial Flora and Vaginal Acidity |
| US7708988B2 (en)* | 1998-08-24 | 2010-05-04 | Ganeden Biotech, Incorporated | Probiotic, lactic acid-producing bacteria and uses thereof |
| US20130101678A1 (en)* | 2007-11-30 | 2013-04-25 | Toltec Pharmaceuticals, Llc | Compositions and Methods for Treating Vaginal Infections and Pathogenic Vaginal Biofilms |
| CN103768095A (en)* | 2013-12-31 | 2014-05-07 | 哈尔滨欧替药业有限公司 | Compound chloramphenicol vaginal swelling suppository, as well as preparation method and detection method thereof |
| US20160143962A1 (en)* | 2014-11-25 | 2016-05-26 | Epiva Biosciences, Inc. | Probiotic compositions containing clostridiales for inhibiting inflammation |
| US20170071990A1 (en)* | 2014-05-16 | 2017-03-16 | Pizeta Group Srl | Compositions containing boric acid and a mixture of lactobacillus |
| US20170312228A1 (en)* | 2014-11-27 | 2017-11-02 | Capsugel Belgium Nv | Dosage form articles for external mucosal applications |
| US10258567B1 (en)* | 2016-11-17 | 2019-04-16 | Grace Procurements Llc | Vaginal probiotic products and related processes |
- 2018
- 2018-05-23USUS15/987,729patent/US12011469B2/enactiveActive
- 2024
- 2024-06-13USUS18/741,897patent/US20240325470A1/enactivePending
Patent Citations (10)
| Publication number | Priority date | Publication date | Assignee | Title |
|---|---|---|---|---|
| US7708988B2 (en)* | 1998-08-24 | 2010-05-04 | Ganeden Biotech, Incorporated | Probiotic, lactic acid-producing bacteria and uses thereof |
| WO2003080813A2 (en)* | 2002-03-21 | 2003-10-02 | Bifodan A/S | Lactobacillus strains |
| US20050053648A1 (en)* | 2003-09-08 | 2005-03-10 | Chalmers Anne Marie | Medication delivery device |
| US20080193428A1 (en)* | 2005-04-27 | 2008-08-14 | Shenzhen Phlora Biotechnology Limited | Composition and Method for Modulating and Maintaining Vaginal Bacterial Flora and Vaginal Acidity |
| US20130101678A1 (en)* | 2007-11-30 | 2013-04-25 | Toltec Pharmaceuticals, Llc | Compositions and Methods for Treating Vaginal Infections and Pathogenic Vaginal Biofilms |
| CN103768095A (en)* | 2013-12-31 | 2014-05-07 | 哈尔滨欧替药业有限公司 | Compound chloramphenicol vaginal swelling suppository, as well as preparation method and detection method thereof |
| US20170071990A1 (en)* | 2014-05-16 | 2017-03-16 | Pizeta Group Srl | Compositions containing boric acid and a mixture of lactobacillus |
| US20160143962A1 (en)* | 2014-11-25 | 2016-05-26 | Epiva Biosciences, Inc. | Probiotic compositions containing clostridiales for inhibiting inflammation |
| US20170312228A1 (en)* | 2014-11-27 | 2017-11-02 | Capsugel Belgium Nv | Dosage form articles for external mucosal applications |
| US10258567B1 (en)* | 2016-11-17 | 2019-04-16 | Grace Procurements Llc | Vaginal probiotic products and related processes |
Non-Patent Citations (5)
| Title |
|---|
| Clinical Infection Diseases 1996: 22:726-7. |
| Cribby S, Taylor M, Reid G., Vaginal Microbiota and the Use of Probiotics: Interdisciplinary Perspectives on Infectious Diseases 2008; 2008:256490. |
| English translation of CN-103768095-A (Year: 2014).* |
| Ogbolu, David & Oni, Anthony & Daini, Oluwole & Oloko, A.P . . . In Vitro Antimicrobial Properties of Coconut Oil on Candida Species in Ibadan, Nigeria. Journal of medicinal food. 10. 384-7. (Year: 2007).* |
| Prutting (Infectious Diseases in Obstetrics and Gynecology 6:191-194 (1998)).* |
Also Published As
| Publication number | Publication date |
|---|---|
| US20180339003A1 (en) | 2018-11-29 |
| US20240325470A1 (en) | 2024-10-03 |
Similar Documents
| Publication | Publication Date | Title |
|---|---|---|
| RU2587717C2 (en) | Effervescent composition in solid form for use in vaginal applications for treating vaginal infections | |
| EP3810088B1 (en) | Improving health of the microbiome in a human gastrointestinal system and multi-chamber probiotic delivery products therefor | |
| KR20170053733A (en) | Prebiotic formulations and methods of use | |
| CN105263504A (en) | Composition comprising lactic acid bacteria for use in the preventive and/or curative treatment of bacterial vaginosis | |
| US8980303B2 (en) | Antimycotic and prebiotic pharmaceutical composition and a method for treating candidal vaginitis | |
| US20210268051A1 (en) | Methods of using smectite compositions for treating clostridium difficile associated diseases and symptoms | |
| CN108611295B (en) | A kind of Bacteroides fragilis for relieving endotoxin infection and its application | |
| US20200155621A1 (en) | Mucoadhesive sustained-release vaginal tablet | |
| CN102106925B (en) | Medlar polysaccharide and bifidobacterium synbiotic colonic targeting microecological regulator | |
| RU2354385C2 (en) | Pharmacological composition for treatment of candidose vulvavaginates | |
| US20240325470A1 (en) | Parenteral delivery device and methods of use | |
| WO2022001673A1 (en) | Novel use of n-acetyl-d-glucosamine and related product | |
| EP1072258A1 (en) | Capsule for the release of bacteria, containing lyophilised bacteria and a method for the production thereof | |
| CN108641980B (en) | It is a kind of to alleviate the bacteroides ovatus and its application that endotoxin infects | |
| RU2491941C1 (en) | Composite enterosorbent | |
| US12109195B2 (en) | Compositions and methods for treatment of vaginal infections | |
| RU2732244C2 (en) | Compositions for treating candidiasis infections | |
| CN101028288A (en) | Health-care mask | |
| CN107837274A (en) | A kind of purposes of diet fiber composition | |
| CN115279383A (en) | Clostridium prasuum strain CNCM I-4573 and PENTASA for treating and preventing gastrointestinal inflammation®In combination with (1) | |
| UA69824U (en) | Composite enterosorbent | |
| CN119552773A (en) | A kind of Lactobacillus crispatus M58D and composition thereof | |
| WO2024009689A1 (en) | Bowel movement ameliorant | |
| JP2021014422A (en) | Defecation improver |
Legal Events
| Date | Code | Title | Description |
|---|---|---|---|
| FEPP | Fee payment procedure | Free format text:ENTITY STATUS SET TO UNDISCOUNTED (ORIGINAL EVENT CODE: BIG.); ENTITY STATUS OF PATENT OWNER: SMALL ENTITY | |
| AS | Assignment | Owner name:VIREO SYSTEMS, INC., TENNESSEE Free format text:ASSIGNMENT OF ASSIGNORS INTEREST;ASSIGNORS:FAULKNER, MARK C.;SEYMOUR, DEEANNAH;REEL/FRAME:045902/0222 Effective date:20180524 | |
| FEPP | Fee payment procedure | Free format text:ENTITY STATUS SET TO SMALL (ORIGINAL EVENT CODE: SMAL); ENTITY STATUS OF PATENT OWNER: SMALL ENTITY | |
| STPP | Information on status: patent application and granting procedure in general | Free format text:DOCKETED NEW CASE - READY FOR EXAMINATION | |
| STPP | Information on status: patent application and granting procedure in general | Free format text:NON FINAL ACTION MAILED | |
| STPP | Information on status: patent application and granting procedure in general | Free format text:NON FINAL ACTION MAILED | |
| STPP | Information on status: patent application and granting procedure in general | Free format text:RESPONSE TO NON-FINAL OFFICE ACTION ENTERED AND FORWARDED TO EXAMINER | |
| STPP | Information on status: patent application and granting procedure in general | Free format text:FINAL REJECTION MAILED | |
| STPP | Information on status: patent application and granting procedure in general | Free format text:ADVISORY ACTION MAILED | |
| AS | Assignment | Owner name:FIRSTBANK, TENNESSEE Free format text:SECURITY INTEREST;ASSIGNORS:VIREO SYSTEMS, INC.;FAULKNER, MARK C;REEL/FRAME:053579/0498 Effective date:20200814 | |
| STPP | Information on status: patent application and granting procedure in general | Free format text:NON FINAL ACTION MAILED | |
| STPP | Information on status: patent application and granting procedure in general | Free format text:RESPONSE TO NON-FINAL OFFICE ACTION ENTERED AND FORWARDED TO EXAMINER | |
| STPP | Information on status: patent application and granting procedure in general | Free format text:FINAL REJECTION MAILED | |
| STPP | Information on status: patent application and granting procedure in general | Free format text:RESPONSE AFTER FINAL ACTION FORWARDED TO EXAMINER | |
| STPP | Information on status: patent application and granting procedure in general | Free format text:ADVISORY ACTION MAILED | |
| STPP | Information on status: patent application and granting procedure in general | Free format text:DOCKETED NEW CASE - READY FOR EXAMINATION | |
| STPP | Information on status: patent application and granting procedure in general | Free format text:NON FINAL ACTION MAILED | |
| STPP | Information on status: patent application and granting procedure in general | Free format text:RESPONSE TO NON-FINAL OFFICE ACTION ENTERED AND FORWARDED TO EXAMINER | |
| STPP | Information on status: patent application and granting procedure in general | Free format text:DOCKETED NEW CASE - READY FOR EXAMINATION | |
| STPP | Information on status: patent application and granting procedure in general | Free format text:NON FINAL ACTION MAILED | |
| STPP | Information on status: patent application and granting procedure in general | Free format text:RESPONSE TO NON-FINAL OFFICE ACTION ENTERED AND FORWARDED TO EXAMINER | |
| STPP | Information on status: patent application and granting procedure in general | Free format text:NOTICE OF ALLOWANCE MAILED -- APPLICATION RECEIVED IN OFFICE OF PUBLICATIONS | |
| ZAAB | Notice of allowance mailed | Free format text:ORIGINAL CODE: MN/=. | |
| STPP | Information on status: patent application and granting procedure in general | Free format text:PUBLICATIONS -- ISSUE FEE PAYMENT RECEIVED | |
| STPP | Information on status: patent application and granting procedure in general | Free format text:PUBLICATIONS -- ISSUE FEE PAYMENT VERIFIED | |
| STCF | Information on status: patent grant | Free format text:PATENTED CASE |